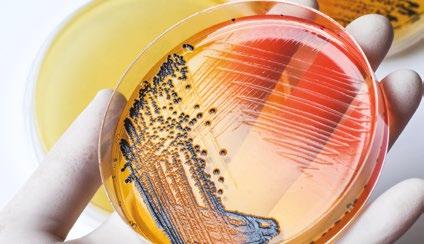
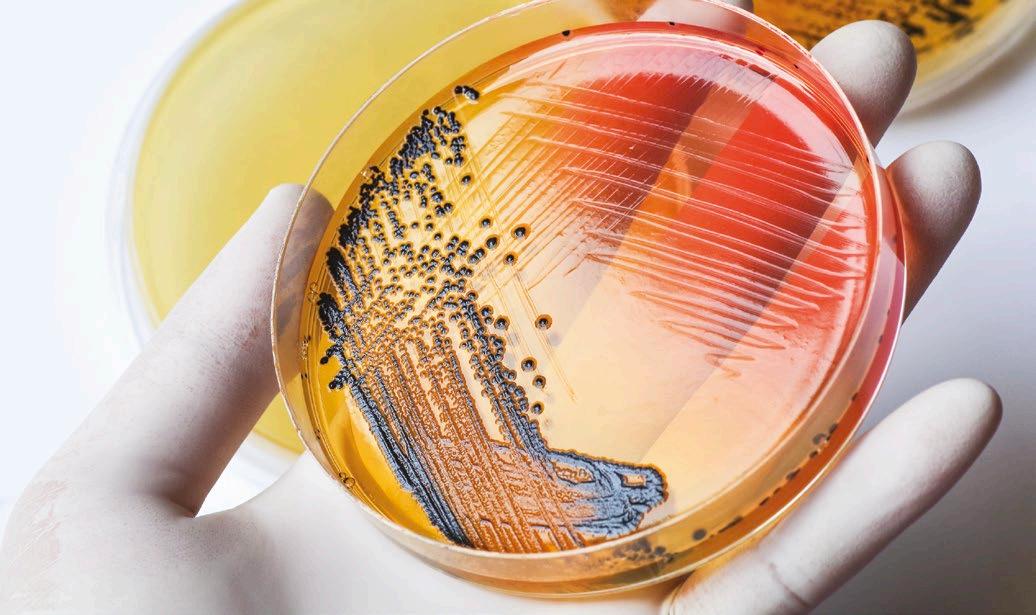

La revista avícola en español leída en más países
Nº 770

La revista avícola en español leída en más países
Nº 770
p. 23
Ventilación de los gallineros en invierno
p.6 p.13
Transporte de pollitos (1)
p.31 p.42
Enfoques plurisdiciplinarios para alcanzar los objetivos de “UNA SOLA SALUD”
Prolapso en gallinas ponedoras: revisión de las condiciones que lo provocan y estrategias de prevención





BIG DUTCHMAN cuenta con todos los accesorios y la tecnología necesaria para construir granjas avícolas listas para entregar. Especialistas en ventilación, calefacción y sistemas de control, también desarrollan su propia tecnología en comederos, sistemas de refrigeración, distribución de pienso o iluminación.


La ventilación por sistema combi-túnel llevada a las máximas exigencias de cada clima genera grandes resultados a sus clientes. Cuentan con la experiencia y los materiales necesarios para adaptarse a las necesidades de cada cliente, tanto en medidas como en sistemas de climatización y control.

No es noticia … y ya lo sabemos, pero no podemos dejar de referirnos a ello: el “estratosférico” aumento del precio del huevo que, en toda la larga vida de este medio, a lo largo de más de 60 años, no habíamos presenciado nunca.
Reflejando en el adjunto gráfico (MAPA, enero 2023) el precio de los huevos en España del año pasado y de varios anteriores, el titular de nuestro comentario editorial es bien evidente. Y aunque por falta de espacio no podemos añadir lo indicado por la misma fuente de que en la media de la UE los precios de los huevos aún han sido casi un 20 % superiores a los del mercado español , en el otro gráfico inferior mostramos el índice del Rabobank que confirma esta información para todo el mundo, en comparación con el de los alimentos en general, también al alza, pero mucho menos.

La situación, pues, no es exclusiva de España y se da globalmente en todo el mundo, pero no por igual porque en Estados Unidos (que se analiza por separado en un artículo incluido en este número) la subida aun ha sido más elevada.
En cuanto a las causas de este fenómeno, que en el antes citado índice bancario se califica de “histórico”, nosotros diríamos que ha sido por la confluencia de los siguientes aspectos que han influido en una reducción del suministro global de huevos:
la grave situación mundial en cuando a la propagación de la influenza aviar (AI), con la consiguiente mortalidad y las medidas de despoblación que ha habido que implementar, el alza en los costes de la alimentación, las fuentes de energía y las más estrictas medidas de bioseguridad implementadas en las granjas,

los cambios regulatorios en algunos países (Alemania y Francia, por ejemplo), que han reducido las producciones comunitarias y
la posible especulación de algunos que, en base a estas circunstancias, han querido sacar provecho de la situación para compensar las pérdidas de ejercicios anteriores.
En relación con la posible especulación, aparte de lo que se apunta en el citado artículo sobre EE.UU., añadiremos que un informe posterior muestra que la significativa reducción en su parque nacional de puesta ha hecho que, por ejemplo, los ingresos netos de la mayor empresa productora de huevos se hayan casi triplicado en relación con los del mismo período del año anterior, sin guardar relación con los aumentos de costes que han tenido que soportar.
Y en lo que se refiere concretamente a España, si bien no podemos hablar de falta de abastecimiento en los mercados y los supers, ¿qué decir acerca del “racionamiento” en las compras (10 docenas por cliente) en una de las más importantes cadenas de alimentación catalanas? ¿Temor de acaparamiento o reducción real de la producción …?
La contestación a esta pregunta no es fácil porque si bien las reposiciones de pollitas para la puesta en los dos últimos meses del 2022 muestran un perfil similar que el de los dos años anteriores, en el trimestre anterior había tenido lugar un incremento del 16 % en este índice, lo que demuestra que ahora, en nuestro caso, no podamos hablar de una reducción de la oferta. Pero, si no es esto, atención al alza pues, aunque sea comprensible el interés de la producción por resarcirse de los ejercicios negativos y pese a que la demanda del huevo sea muy elástica, todo tiene un límite y no es cuestión de tensar tanto la cuerda ….
Real Escuela de Avicultura
Nº 770
3
6
13
21
EDITORIAL
Los huevos, por las nubes
PRODUCCIÓN DE CARNE
Ventilación de los gallineros en invierno
Martijin Gruyters
Transporte de pollitos
EFSA Journal
TENDENCIAS
La incertidumbre actual obstaculizará el crecimiento de la proteína animal en 2023

Global Animal Protein Outlook 2023
23
Robótica y “Big data” para la agricultura de precisión


Thomas Norton
31
37
40
SALUD AVIAR
Enfoques plurisdiciplinarios para alcanzar los objetivos de “UNA SOLA SALUD”
Susan Lamont
Mantenerse al día con la coccidiosis sigue siendo un reto de la resistencia
Philip A. Stayer
NUTRICIÓN
Mantenimiento de un equilibrio entre la calidad del pienso, la digestibilidad de los nutrientes y los objetivos de la producción
Wilmer J. Pacheco
42
PRODUCCIÓN DE HUEVOS
Prolapso en gallinas ponedoras: revisión de las condiciones que lo provocan y estrategias de prevención
Rafael Lera
51 60 62
61 63 64 64
DE HUEVOS
Casos humanos de Influenza dudosos y nuevos protocolos oficiales

María del mar Fernández Poza. Directora de ASEPRHU
Inprovo arranca el 2023 con la agenda llena…
R.D. de medidas anticrisis: 0% de IVA en huevos y alimentos básicos
Aprobado el R.D. que regula el registro de contratos alimentarios
Aprobada la campaña europea de promoción “Los juegos del huevo” cofinanciada por la UE
El IEH lidera el grupo operativo “Sustainavility”, que apoya la innovación en avicultura
Mas noticias positivas sobre el huevo en los medios
La IEC celebrará su próxima Conferencia en Barcelona
Estudios sobre la entrada vía aérea del virus de la Influenza Aviar en Granjas
Efectos del suministro de agua a las gallinas a través de una canalización de PVC o bien de cobre
Tratamiento electrolítico del agua de bebida en época de calor
Publicado el Programa Nacional de control de Salmonella en pollos para 2023
La fábrica de CASCAJARES, abrasada por un incendio
PROCAVI invertirá 30 M de Euros para la ampliación y modernización de sus instalaciones

Josep Solé, elegido nuevo Presidente de AVIANZA
65 CLASIFICADOS
Cómo mantener las temperaturas objetivo para los pollos sin perder la calidad óptima del aire.
Los progresos en materia de la genética, la nutrición y el manejo han conducido a unas notables mejoras en el crecimiento y la transformación alimenticia de los pollos modernos, con el beneficio añadido de una tremenda reducción en el tiempo que tardan hoy en alcanzar su peso comercial. Por lo tanto, por cada hora en que las aves pasan sin estar a una temperatura
Martijin GruytersCanadian Poultry, 109: 10, 20-24. 2022

y ventilación óptimas se pierde en rendimiento.
El mayor reto con el que se enfrenta cualquier productor son los requisitos dinámicos de la zona de confort durante la vida de los pollos, que también dependen del lugar y la época del año. Sin embargo, durante el invierno, cuando las temperaturas exteriores bajan significativamente, hay el gran reto de mantener las temperaturas objetivo sin perder en la calidad del aire.

Es casi imposible ventilar o controlar adecuadamente la temperatura de un gallinero si no está bien aislado. Cualquier grieta, un cierre defectuoso en las persianillas de los, ventiladores, o un defectuoso aislamiento en la cubierta reducirán la capacidad de controlar la presión estática de la nave, lo que hará que una cierta proporción de aire fresco entrará en ella a través de estos puntos.
Ello significa que se requiera una mayor capacidad de ventilación para lograr el volumen y la velocidad de aire correctos a través de las entradas y origina un aumento de los costes de calefacción. Además, será difícil mantener las temperaturas objetivo, especialmente de noche, aparte de que las fugas son fuentes de corrientes de aire frío que, a su vez, pueden causar problemas de salud a las aves y unas camas húmedas.

La mayoría de los ventiladores laterales modernos tienen persianas montadas en el interior, que se pueden sellar con una lámina de plástico colocada entre las mismas y el marco durante el invierno. Los mayores ventiladores de cono y cajones más grandes, utilizados para la ventilación de verano, también se pueden sellar con una cubierta de plástico por su parte exterior. La presión negativa creada en la nave empujará el plástico contra las persianillas del ventilador para ayudar al sellado. Las puertas grandes también se sellan fácilmente colocando una gran lámina de plástico en su parte exterior.
La siguiente es una prueba de evaluación de presión muy simple. Los ventiladores utilizados para la prueba se basan en la superficie del piso de la nave:
1. Cerrar todas las entradas y puertas.
2. Calcular el equivalente a 18 m3/h de capacidad de ventilador por m2 de superficie (por ejemplo, 2.000 m2 × 18 m3/h = 36.000 m3/h de capacidad de ventilación). Aunque dependiendo de los ventiladores instalados no siempre es posible obtener una ajuste perfecto.
3. Medir la presión estática en cualquier abertura pequeña, como una entrada o un orificio ligeramente abierto.

Una presión estática de más de 37,5 Pa indica que la nave está adecuadamente sellada, pero si es menor de 25 Pa es que está mal, lo que requerirá corregirse. Una nave recién construida debe alcanzar fácilmente una presión estática de 60 Pa. Siempre hay que registrar los resultados de sus pruebas de presión para una referencia futura.
Los sistemas de ventilación mínima están diseñados para gestionar los niveles de calidad del aire y humedad utilizando ventiladores con un temporizador. Este sistema es independiente del control de la temperatura y debe diseñarse y operarse de tal forma que mantenga una buena calidad del aire y un control de la humedad para un desarrollo óptimo de los pollos.
Con una ventilación mínima, hay tres factores principales a considerar.
1. En primer lugar, la continua mejora genética da como resultado mayores tasas metabólicas y de crecimiento que, a su vez, aumentan la demanda de oxigen. Este aumento de las mismas también significa una mayor producción de calor metabólico, de la humedad depositada en la cama a través las deyecciones y de los niveles de producción de dióxido de carbono, todo lo cual debe eliminarse mediante una ventilación mínima.
2. En segundo lugar, debido al aumento del tiempo de funcionamiento de la calefacción durante el invierno se pondrá más estrés en el sistema de ventilación mínima, ya que se produce más gas residual por la misma.
3. Por último, durante el invierno hay una tendencia de los criadores a reducir los niveles mínimos de ventilación como medio de mantener la temperatura y reducir los costes de energía, lo que puede originar una mala calidad del aire.
Los parámetros de calidad del aire para las aves domésticas pueden resumirse en:

Oxígeno (O2)
por encima del mínimo 19,6%
Dióxido de carbono (CO2) máximo de un 0,3% (3,000 ppm)
Monóxido de carbono (CO) máximo 10 ppm
Amoníaco (NH3) máximo 10 ppm
Polvo inspirable menos de 3,4 mg/m3
Humedad relativa (HR) menos del 70%
Durante el invierno, es especialmente difícil cumplir con los parámetros de calidad del aire debido al dilema de mantener la temperatura y la calidad óptima del aire. Cuando la capacidad de calefacción es limitada, hay una tendencia a reducir la ventilación mínima para evitar la pérdida de calor. Al mismo tiempo, los niveles de CO y de HR aumentan, lo que tiene un impacto negativo en el desarrollo de los pollos y el estado de la yacija. La correcta programación de una ventilación mínima es el único método eficaz para controlar estos parámetros.
El oxígeno es un componente importante en los procesos fisiológicos, y las aves requieren un nivel mínimo para un rendimiento óptimo. En un gallinero, el CO2 se agrega continuamente al medio ambiente por parte de las aves y el sistema de calefacción, especialmente en invierno y el uso constante de ésta. Los niveles de CO2 deben mantenerse por debajo de lo señalado ya que su aumento desplazaría al oxígeno. Cuando son superiores la disponibilidad de oxígeno será baja, lo que originará unas aves inactivas, una menor ingesta de pienso y agua y un mayor riesgo para el desarrollo de ascitis.
Al igual que el CO, la humedad se agrega a un gallinero principalmente por las parte de las aves y los sistemas de calefacción, aquellas a través de la respiración, la bebida y las deyecciones, mientras que la combustión de 1 m3 de gas añade un litro de vapor de agua al aire. Si esta humedad adicional no se elimina de la nave, la HR aumentará y causará problemas de yacija húmeda.

La HR debe mantenerse por debajo del 70% siempre que sea posible. El único medio para eliminar el exceso de humedad es aumentando la temperatura del aire y el intercambio de aire. A medida que aumenta la temperatura del aire, su capacidad de retención de humedad también aumentará, con el consiguiente aumento significativo de la que se puede eliminar mediante una ventilación mínima.
Consultar esta lista para prepararse para el invierno
• Sellar adecuadamente todos los ventiladores que no se utilizan durante la ventilación durante el invierno.
• Sellar las entradas del túnel cuando no se utilicen durante el invierno.
• Realizar una prueba de fugas para verificar el sellado de la nave.
• Asegurarse de que todas las entradas estén completamente cerradas.
• Comprobar todos los conectores y cables de nylon. Cualquier conector que esté roto o de mala calidad debe ser reemplazado.
• Asegurarse de que las puertas de entrada sellan bien o adecuar un sellado adicional al recibir a los pollos.
• Comprobar la configuración del sistema operativo y de que esté configurado para el invierno (por el aire frío, la HR, etc.).
La revista avícola española leída en más países www SeleccionesAVICOLAS.com
Edita: Real Escuela de Avicultura
Director: Fernando Castelló fcastello@avicultura.com
Colaboradores:
Jesús L. López Aznar Geer t-jan Camps
Carlos Terraz José A. Castelló
Diana V Bourasa Mar Fernández
Federico Castelló Ricardo Cepero
Elías F Rodríguez Ferri Peter Van Horne
Diseño y maquetación: Iplanning info@iplanning.es
Publicidad y Marketing: Real Escuela de Avicultura fcastello@avicultura.com
Suscripciones y atención al cliente: contabil@avicultura.com
Dpto atención al suscriptor Real Escuela de Avicultura BARCELONA (España)
Tel. +34 93 115 44 15 www.avicultura.com contabil@avicultura.com
Depósito legal:
B. 429 - 1959. ISSN 0210 - 0541
2023
Sobre la Real Escuela de Avicultura:
La avicultura, nuestra pasión.
Observamos Analizamos Explicamos
La Real Escuela de Avicultura, observa, analiza y explica todo lo que preocupa y ocupa a los profesionales del sector avícola, divulgando este conocimiento así como las tendencias del sector fruto de su observación e interacción con granjeros, técnicos, empresas, administración y las demandas de la sociedad
Esta actividad divulgativa es posible gracias al apoyo de sus suscriptores, anunciantes y asistentes a sus Jornadas y cursos
La revista SELECCIONES AVÍCOLAS publica artículos originales y reproduce trabajos presentados en otros medios de comunicación. Los artículos originales deben reunir unos determinados requisitos, que se indicarán a los interesados. Los artículos no originales provienen de trabajos presentados en congresos y simposios nao de divulgación, o de estudios publicados por centros experimentales de todo el mundo, para lo cual cuenta con expresa autorización
SELECCIONES AVÍCOLAS, fundada en 1959 por Federico Castelló de Plandolit, es continuación de la primera revista avícola en castellano publicada en el mundo, «Avicultura Práctica», editada en 1896 por el Prof Salvador Castelló

Las ensenadas son posiblemente la parte más importante del sistema de ventilación de una nave. La colocación y el diseño de las mismas afectarán significativamente la dirección del aire frío entrante. En muchas regiones las temperaturas del aire exterior en invierno son bajas con niveles potencialmente altos de HR. Este aire frío y húmedo necesita ser calentado antes de alcanzar el nivel de las aves.
Pero debido a la estratificación del aire las temperaturas del mismo son siempre más altas en el techo o en la cúspide de la nave. Por tanto, el aire frío y húmedo entrante debe dirigirse a este lugar y mezclarse con el aire caliente antes de alcanzar el nivel de las aves.
En los climas fríos las entradas de aire solo deben abrirse desde la parte superior, dirigiendo el aire entrante a la cúspide de la nave. Las entradas mal selladas y diseñadas con rendijas por los lados o la base dirigen una cantidad significativa de aire frío y pesado hacia el piso, lo que es una fuente de corrientes y yacija húmeda.
La apertura de las entradas de aire siempre debe coincidir con la capacidad de los ventiladores y generalmente tener una sección mínima de 5 cm para producir un chorro de aire óptimo. Una abertura más pequeña no producirá un chorro de aire lo suficientemente fuerte como para llegar al centro de la nave. Para una distribución óptima del aire, el entrante necesita una superficie lisa para fluir a fin de garantizar que llegue al centro de la nave donde pueda mezclarse con el aire caliente en el pico del techo.
Durante el inicio de la crianza no todas las entradas se utilizan para que se logre la apertura mínima de 5 cm. Lo mejor es asegurarse siempre de que las entradas opuestas estén abiertos o cerrados para un flujo de aire óptimo. Cualquier entrada que no esté en uso debe estar completamente cerrada porque las fugas causan pérdidas de presión.
Las aberturas de entrada deben controlarse a presión para mantener un flujo de aire constante a diferentes capacidades de ventilación. Cuando se utilicen cables para operarlas hay que prestar una especial atención a los cables de nylon que las cierran ya que pueden estirarse y causar unas aberturas desiguales, recordando que las que no se cierran completamente causarán pérdida de presión y de energía.
A solicitud de uno de los autores del artículo “Empleo de la nebulización como complemento de los paneles de refrigeración evaporativa en las naves de broilers”, publicado en el número de septiembre del 2021 en SELECCIONES AVÍCOLAS, hacemos constar un error en la traducción del término “sprinklers”, que nosotros interpretamos como “nebulizadores”, cuando el correcto era “aspersores”.

EFSA JOURNAL, 20-6-22

Tradicionalmente, los pollitos para carne y las pollitas de puesta eclosionan en las plantas de incubación después de haber pasado en las incubadoras unos 21 días, con los 18 primeros en una máquina y los 3 últimos en otra (la “nacedora”). El tiempo de eclosión (la "ventana de eclosión"), puede estar entre 24 y 48 h, dependiendo de la edad de los reproductores, el manejo y el tiempo de almacenaje de los huevos y las condiciones de incubación, lo que puede originar una diferencia de edad entre los pollitos en el mismo lote de un día o más.
Cuando nacen, los pollitos se someten a un período de espera, generalmente sin acceso al pienso y al agua, antes de ser transportados a
las granjas. Sin embargo, en algunos sistemas de crianza alternativos (por ejemplo, el “Patio”), los huevos en incubación se llevan a la granja y eclosionan allí, lo que hace que los pollitos recién nacidos no son transportados.
El actual Reglamento de transporte de la UE (CE 1/2005) no establece un tiempo máximo de viaje para el transporte de los pollitos, pero exige que dispongan de alimentos y agua, salvo en el caso de un viaje de menos de 24 h para pollitos de todas las especies, siempre que se complete dentro de las 72 h después de la eclosión.
Es importante reconocer la naturaleza única del transporte de los pollitos recién nacidos pues no se
transporta ninguna otra especie en el período postnatal inmediato. Esto puede realizarse gracias a que los pollitos llevan el vitelo, una reserva de nutrientes, que comprende alrededor del 18% de su peso y es una fuente que proporciona energía y proteína para su mantenimiento y el crecimiento. Sin embargo, los pollitos para carne se han seleccionado, en parte, para unos niveles metabólicos anormalmente altos, por lo que el vitelo puede ser nutricionalmente insuficiente para estos fines pues aunque su absorción debería permitirles sobrevivir al menos un corto tiempo, ello es un reto importante.

El transporte de pollitos consta de cinco pasos.
La preparación, con la planificación del viaje y la evaluación de la aptitud para el mismo.
La carga de los pollitos en sus cajas y la carga de estas en un vehículo.
El viaje en sí, con el traslado en un vehículo hasta llegar al destino.
La llegada a la granja de destino, con la descarga de las cajas.
La descarga de los pollitos de las cajas.
Después de la eclosión, los pollitos se toman de las bandejas de nacimientos y se separan de las cáscaras de los huevos y otros restos, se separan los de “segunda”, se vacunan, a veces se sexan, se cuentan y se introducen en sus cajas de transporte, todo ello en un período de 2 a 4 h, aunque en algunos casos también pueden ser sometidos a un recorte de picos o de los dedos en el mismo lugar. Todo ello generalmente se realiza mediante sistemas automatizados sobre cintas transportadoras de alta velocidad que transportan a los pollitos a través de la planta de incubación, habiéndose demostrado que en general es estresante y puede tener consecuencias a largo plazo en el comportamiento y la reactividad al estrés.

La planificación del transporte, incluida la decisión sobre la capacidad de las cajas y la determinación de la duración del viaje y el número de paradas, es parte de la etapa de preparación del transporte.
Tradicionalmente, los pollitos no reciben comida ni agua desde la eclosión hasta que llegan a la granja, aunque se puede proporcionar un gel acuoso en algún transporte largo (por ejemplo, en el transporte aéreo) y para los pollitos de codorniz.
Las principales condiciones que hacen que los pollitos no sean aptos para el transporte son una mala calidad de los mismos, una Incapacidad para estar de pie, fracturas de piernas y alas y luxaciones.
La puntuación de Pasgar se puede utilizar para determinar
la calidad de los pollitos sobre la base de 5 criterios: el estado del ombligo (negro o abierto), un gran tamaño del saco vitelino residual, unos tarsos rojos o hinchados, un pico anormal (rojo o con las fosas nasales contaminadas con albumen) y un bajo estado de alerta.
Tona y col. (2003) publicaron otro sistema para evaluar la calidad de los pollitos, con la principal diferencia con la puntuación de Pasgar siendo la adición del estado ocular, del plumaje, las patas y del ombligo. De acuerdo con el mismo, los pollitos podrían no ser aptos para el transporte cuando están sucios y húmedos, muestran un vientre hinchado y duro, los ojos cerrados, unas patas infectadas y un ombligo no cerrado y decolorado.
Se emplean cajas de transporte, de plástico o desechables con un tamaño estándar de 60 × 40 × 12 cm, para 90 pollitos en circunstancias normales, lo que representa un espacio de 26,7 cm2 por pollito., aunque los faisanes y perdices recién nacidos se manipulan y se colocan en unas cajas menores. Pero en todo caso las densidades se pueden ajustar de acuerdo con las condiciones climáticas.
El embalaje de los pollitos suele ser automático, a través de una cinta transportadora que los coloca en las cajas. Luego, apiladas en carros, dejando espacio entre ellas para la ventilación y se colocan en una sala de espera con la temperatura generalmente controlada hasta la carga en un vehículo.

Los vehículos utilizados para el transporte de pollitos suelen estar equipados con aire acondicionado, así como sensores de temperatura, humedad y gas para el control ambiental dentro de ellos.
Una vez cargados en el vehículo, las cajas con los pollitos pueden ser transportadas directamente a la granja, donde son descargados, o pueden someterse a diferentes paradas para el reparto a otras granjas, dependiendo del tipo de producción y

del número de animales a entregar.
Según Lambrecht y col. (2020) el transporte de pollitos en Bélgica dura en promedio 1,5 h, pero puede durar hasta 11 h y el empleo de un solo vehículo para diferentes granjas significa que los destinados a la última granja de la ruta experimentan el tiempo de viaje más largo. (Este trabajo fue publicado en dos partes, en los números de julio y agosto de 2022 de SELECCIONES AVÍCOLAS).
Fig. 1. Caja de plástico utilizada para el transporte de pollitos (Malcolm Mitchell)A su llegada, los pollitos generalmente se descargan sin demora. De hecho, en caso de entrega parcial, el vehículo tiene que continuar el viaje; por lo tanto, las cajas que deben permanecer en la granja se descargan lo antes posible en cada parada. No se ha realizado ninguna investigación sobre el manejo de los pollitos a su llegada, cuando pueden ser suavemente inclinados o retirados manualmente de las cajas de transporte. Su manejo puede tener efecto en el bienestar, al igual que la forma en que está preparada la nave, con su temperatura y el acceso al pienso y al agua, lo que tendrá un efecto en el bienestar y la salud de los pollos .
Sin embargo, en un intento de identificación de las consecuencias más relevantes del transporte para el bienestar de los pollitos en
cada etapa del mismo se han detectado el estrés del manejo, la sobreestimulación sensorial, la tensión del movimiento, el estrés por calor o por frío y el hambre o la sed prolongados. Todas ellas empeoran con un
El estrés del manejo de los pollitos se refiere sus afectos negativos, como el dolor y / o el miedo a consecuencia del trato humano o mecánico que han tenido desde su nacimiento hasta que se descargan de las cajas en la granja.
En primer lugar, está el proveniente de su retirada de la nacedora hasta el momento en que son introducidos en las cajas de envío, lo que generalmente se realiza mediante sistemas automatizados sobre rodillos y cintas transportadoras de

alta velocidad. No se sabe de ningún impacto de los procesos de incubación en el bienestar de los pollitos, pero el aumento de las alturas de caída y la aceleración de la cinta transportadora conducen a su desorientación e incomodidad, por cuya razón el estrés de la manipulación se considera alto, con una gravedad variable, dependiendo del número y los procedimientos de manipulación, y su duración.
Los estudios farmacológicos y conductuales de laboratorio relacionan la expresión
aumento de la duración del viaje. Las principales causas de pérdidas en el tránsito y la mortalidad y morbilidad posteriores al transporte son la deshidratación y la desnutrición (Xin y Lee, 1997).
de la llamada de socorro con un estado afectivo negativo. Como tal, existe una expectativa a priori de que las llamadas de socorro en las granjas indiquen no solo un bienestar físico, sino también emocional.
La orientación y la postura de los pollitos en la cinta transportadora de la planta de incubación, así como los intentos de fuga y el aleteo de las alas también pueden ser indicadores de estrés de manejo. La presencia de pollitos en el suelo es una medida simple
de la consecuencia de una configuración inadecuada del transportador y un manejo brusco y, por lo tanto, una fuente de estrés para los pollitos.
El principal peligro es el manejo brusco de los pollitos de forma automática o manual durante su captura, la colocación en las cajas, la carga y la descarga en la granja. Ello incluye un cambios en la velocidad, aceleración y la altura de caída de las cintas transportadoras, un diseño deficiente de los componentes éstas y una manipulación manual brusca.
Los pollos recién nacidos, hasta los 5 a 8 días de edad, se comportan como poiquilotermos, lo que significa que no pueden regular su temperatura corporal por sí mismos. Por lo tanto, se requiere una temperatura efectiva adecuada para mantener la temperatura corporal en el nivel deseado de 40-40,5 ° C. Debido a los requisitos especiales de temperatura de los pollitos durante la primera semana de vida, mantenerlos en su zona de confort térmico es de importancia crítica, de igual forma que el estrés térmico puede ser la consecuencia de bienestar más grave durante su transporte de recién nacidos.
Comparando Vieira y col. (2016) las respuestas termorreguladoras de pollitos recién nacidos expuestos a frío (21°C), calor (38°C) y neutralidad (35°C) durante 1 h en el transporte comercial en contenedores colocados en una cámara ambiental, observaron que
Los orígenes del peligro son el personal y el equipo, que provienen de errores en la operación, un diseño y mantenimiento deficientes de los equipos y unas cintas transportadoras demasiado rápidas o mal sincronizadas. Con la eclosión en la granja, los pollitos no están sujetos a estos procesos de manipulación, lo que constituye la mejor forma para evitar el transporte.
En caso contrario no se puede evitar el estrés de la manipulación, pero se pueden aplicar medidas para mitigarla, entrenando al personal para manipular a los pollos con cuidado y mediante
un monitoreo constante de los embalajes y la carga de las cajas en los vehículo para evitar la caída de los pollitos. El diseño y el mantenimiento adecuados de los sistemas asegurarán que los pollitos no queden atrapados en ninguna parte de ellos. Y si caen al suelo, hay que recogerlos con cuidado a fin de mitigar las consecuencias para su bienestar.
Una iluminación muy brillante, una fuerte aceleración o frenazo en las cintas de transporte, las vibraciones, los ruidos súbito, etc. también son fuentes de estrés y, por lo tanto, deben ser evitados.
su superficie corporal y la temperatura cloacal se redujeron significativamente con el tratamiento en frío, que no hubo ningún efecto significativo con la temperaturas superior y que la posición de la caja tuvo un efecto insignificante en el confort térmico de las aves. Sin embargo, sugieren que con duraciones de viaje más largas, las temperaturas más altas también podrían haber afectado las respuestas termorreguladoras de los pollitos.
En otro estudio (Maman y col., 2019) se expusieron los pollitos durante 12 h a 3 temperaturas diferentes, con una humedad controlada (53-56 %), viéndose que los que tenían la mayor temperatura corporal (42,6 ° C) perdieron una mayor proporción de peso debido a deshidratación y unos pesos de órganos más bajos, a consecuencia de lo cual su rendimiento en el engorde fue peor. Su conclusión fue que los pollitos son más sensibles a temperaturas corporales
más altas que a temperaturas más bajas durante su manejo posterior a la eclosión.
Algunos estudios han intentado definir el ambiente termoneutro para los pollitos recién nacidos en base a la producción de calor metabólico y las respuestas de la temperatura corporal, aunque no midieron los mejoras indicadores de esfuerzo homeostático para definir el efecto fisiológico del microambiente térmico. En cambio, Xin y Harmon (1996) examinando los efectos de unas temperaturas y humedad desde 20 a 35 ° C y del 40 al 17% sobre los pollitos recién nacidos en base al ritmo metabólico y la mortalidad, llegaron a la conclusión de que las condiciones óptimas o termoneutrales se hallan entre 30 y 32 ° C.
Al no haber desarrollado aún un sistema para regular su temperatura corporal, debido a su bajo peso, los pollitos pueden estar sometidos tanto a un estrés por frío como por calor, en dependencia de
las condiciones climáticas externas, la ventilación y el microclima de las cajas de transporte. La incidencia de estas consecuencias para el bienestar puede ser alta en caso de sometidos, durante la espera, la carga/ descarga o el transporte, a unas temperaturas muy frías o demasiado calientes y de su duración ello, pudiendo llegar hasta la muerte (DOA).

a altas temperaturas. La temperatura corporal de un pollito recién nacido está normalmente entre 40 y 40,5 ° C, aunque según Vieira y col. (2016) la medida en la cloaca puede alcanzar los 41,2 °C. En la práctica comercial, la temperatura recomendada para el transporte de los pollitos es de 24 a 26 ° C y la humedad entre el 75% a 24°C
Por estas razones, el estrés por frío y calor se ha seleccionado como una de las consecuencias de bienestar más relevantes para los pollitos.
En el período post-eclosión inmediato la temperatura corporal y el nivel metabólico de los pollitos aumentan, pero aquella permanece lábil durante la exposición durante un ambiente térmico subóptimo debido a su inmadurez para la homeostasis termorreguladora por hipotermia o hipertermia. Por lo tanto, una consecuencia extrema del estrés térmico, combinado o no con otros problemas de bienestar como el retraso en el acceso al pienso y al agua, puede ser la mortalidad.
El estrés por calor es cuando el pollito experimenta estrés y/o un estado afectivo negativo como incomodidad y/o angustia debido a dificultad para mantener la temperatura corporal en la zona de confort térmico cuando se expone
También se ha demostrado que, con un ambiente térmico controlado (30-32 ° C en las cercanías de los pollitos), se pueden realizar viajes de 12 h sin ningún efecto perjudicial debido al estrés por frío. Se estima que tanto la productividad como el bienestar de los pollitos recién nacidos en el viaje pueden mantenerse bien mediante una regulación cuidadosa de la temperatura y la humedad hasta estos límites dentro de las cajas de transporte, aunque en lo referente a esta última hay opiniones diversas. Sin embargo, con el advenimiento de nuevos diseños de los vehículos, las especificaciones térmicas pueden tener que ajustarse a partir de los parámetros de temperatura y humedad antes descritos para igualar unos niveles de ventilación más altas.
En una experiencia en cámaras climáticas sometiendo a los pollitos a estrés por frío y calor durante diferentes tiempos de
exposición se vio que a 38°C y el 75% de humedad hubo un impacto en la frecuencia respiratoria (> 100/min), la temperatura cloacal (44,7°C) y la mortalidad (más del 6 %), especialmente después de las 3 primeras horas de exposición Vieira y col. (2016) en otro experimento utilizado para monitorear tanto el estrés por frío como por calor durante 1 h de duración: temperatura media superficial y cloacal, frecuencia respiratoria, peso corporal y mortalidad. La ABM más afectada fue la temperatura media de la superficie, que fue de 35,1 °C en condiciones termoneutrales (35 °C) y 38,1 °C en condiciones de calor (40 °C). Hay que tener en cuenta que el estrés por frío es, en este experimento, 20 ° C por debajo de la condición neutra y el estrés por calor solo 5 ° C más. Las temperaturas cloacales asociadas fueron, respectivamente, de 40,9 a 41,2 °C en condiciones neutras y de 42,4 a 42,6 °C en condiciones de calor. La frecuencia respiratoria mostró un aumento importante en caso de estrés térmico, de 60 a 66 respiración / min a 225252 en condiciones de estrés por calor, esto probablemente se deba a la reacción de estrés, en lugar del mecanismo de termorregulación. Cabe señalar que en este experimento se consideró una temperatura de 35 ° C como condiciones termoneutrales. En caso de estrés por calor, en los pollitos se pueden observar un aumento de la frecuencia respiratoria, aunque, debido a su baja capacidad de regulación térmica no llegan a jadear.
Teniendo en cuenta los diferentes retos por el calor en las experiencias de Vieira y col. ( 2016 y, 2019) podemos proponer que los pollitos comienzan a experimentar un
ventilación o una exposición al sol, lo que puede suceder durante la carga, el viaje y a la llegada a destino, si las pollitos se dejan en el exterior y sin protección contra el sol, en el asfalto, un patio, etc. Febrero 2023 | N o 770
El ambiente controlado o los vehículos con aire acondicionado pueden regular o modificar las condiciones térmicas internas mediante la calefacción o refrigeración adecuadas. Tienen la ventaja de que el entorno interno puede controlarse con precisión independientemente del clima externo o las condiciones térmicas y no depende del movimiento del vehículo.
Para controlar la temperatura en la cercanía de los pollitos se debe ajustar el calentamiento, aumentar la ventilación o utilizar el aire acondicionado para no pasar de los 35 ° C en el interior de las cajas, lo que podría lograrse alcanzarse con un ambiente en un vehículo clásico de unos 25 ° C y un 60-63% de humedad. Pero hay que tener en cuenta que el ajuste de la temperatura y la humedad podría ser diferente en un vehículo moderno, de acuerdo con sus características de ventilación.

Durante la carga, la llegada y la descarga, cuando los pollitos se someten a la temperatura exterior en condiciones climáticas cálidas, deben protegerse del sol directo y proporcionarles ventilación. Y al cargar en el vehículo, las cajas deben estar espaciadas para permitir la circulación del aire y una buena ventilación, lo que también debe hacerse una vez han sido descargadas, retirándose luego enseguida los pollitos.
En una encuesta en Bélgica realizada por Lambrecht y col. (2020) durante la época de calor, el personal responsable indicó que reducen el número de pollitos en las cajas de 90 a un máximo de 80 para aumentar el espacio por cabeza.
(Continuará)
Se espera que la producción mundial de proteína animal crezca modestamente en 2023, pero que también haya más cambios, lo que genera incertidumbre para los productores. La elevada presión de la enfermedad, los altos costos, las oscilaciones en el consumo y los cambios regulatorios e impulsados por el mercado continuarán enturbiando las perspectivas.

"Ha sido un año como ningún otro para las industrias de la proteína animal. Las empresas han lidiado con el aumento de los precios de los insumos, la interrupción de las cadenas de suministro y los conflictos geopolíticos, muchos de los cuales no se han resuelto a medida que nos adentramos en el 2023", ha dicho Justin Sherrard, estratega global de
Inf. Rabobank, Dic. 2022
proteína animal en Rabobank. "Estos factores han aumentado los costes en todo el mercado, pero aunque los precios suben rápidamente, tienden a caer más lentamente".
Rabobank dice que las oportunidades aún existen, pero serán más restringidas, recomendando que las compañías de proteína animal vean 2023 como "un año para recalibrar sus expectativas y planes de crecimiento".
Se espera que los precios se mantengan altos en 2023, incluso cuando el mercado disfrute de un crecimiento constante de la producción gracias a un creciente suministro de la acuicultura y la avicultura. Esto enmascara las reducciones en el suministro de carne de vacuno, debido a la contracción en Estados Unidos después de años de sequía, y el debilitamiento del mercado de la carne de cerdo en Europa.
El mayor reto para las empresas de proteína animal es cómo abordarán la próxima década de crecimiento, no simplemente el próximo año.
Los cambios estructurales en el mercado, así como el aumento de la conciencia sobre la huella de carbono y un enfoque proactivo para gestionar las enfermedades, ofrecen oportunidades para que las empresas más progresistas inviertan y prosperen. En otras palabras, ahora es el momento de la decisión.
Dadas las presiones actuales, Rabobank dice que las empresas de proteína animal deben elegir un enfoque a corto o largo plazo. Las empresas que opten por centrarse en las presiones cíclicas a corto plazo deben "mantener el rumbo" con las lecciones aprendidas de la pandemia e invertir para mejorar la inteligencia de mercado, desarrollar aún más las redes y leer mejor las señales del mercado y garantizar que los socios puedan cambiar de dirección rápidamente. Por otro lado, las empresas que elijan un enfoque a más largo plazo deben mantener sus ojos en el horizonte "construyendo resiliencia en la cadena de suministro para fortalecer el acceso a los insumos y las conexiones con los clientes, lo que también permitirá la transición de los sistemas de producción y el logro de los objetivos de sostenibilidad".
El impacto de los mayores costos de los insumos varía según la región y la especie, lo que influye en la competitividad, según Rabobank. Los sectores avícola y de la acuicultura tienen la capacidad de manejar el impacto de los costes más fácilmente debido a su eficiente alimentación y a unos ciclos de producción más cortos, pero las carnes de cerdo y de vacuno se enfrentan mayores retos.
Según el informe, los precios mundiales de los granos y las semillas oleaginosas casi se duplicaron (hasta un 94%) de mayo de 2020 a mayo de 2022, debido a una mayor demanda, problemas de suministro continuos y una creciente incertidumbre geopolítica. Rabobank explica que estos desafíos de precios no son sin precedentes, ya que unos vientos en contra similares crearon un aumento del 170% en los precios mundiales de los piensos de 2005 a 2008. Durante ese período de tiempo, los márgenes de los productores de proteína animal se volvieron negativos, y el mismo resultado es posible esta vez, sugiere el informe.
Rabobank espera que los precios en 2023 se mantengan relativamente dentro del rango, ya que los factores principales que llevaron al repunte más reciente permanecen intactos.
La sequía seguirá limitando el crecimiento de los balances de granos y oleaginosas, ya que tres años de un patrón climático de La Niña han limitado la producción mundial. Si bien los pronósticos meteorológicos a largo plazo predicen una transición a un patrón más neutral para el segundo trimestre de 2023, Rabobank dice que un primer trimestre más cálido y seco aún podría provocar sequías en 2023 para el hemisferio norte.
"El aumento vertiginoso de los precios de la energía y el debilitamiento del euro ya están afectando la competitividad de Europa, mientras que la fortaleza del dólar puede afectar a Estados Unidos", señala el informe, añadiendo que los cambios regulatorios e impulsados por el mercado, como la propuesta del gobierno noruego de gravar la acuicultura, también podrían afectar a la competitividad.
En lo referente a la producción europea de carne el informe del Rabobank indica que estará bajo presión en todas las especies debido a los riesgos de enfermedades, los cambios impulsados por el mercado y su regulación, así como una y reducción de las exportaciones. Se espera que el consumo se mantenga estable y que la carne de ave se beneficie, mientras que las de cerdo y de vacuno se reduzcan ligeramente.
Finalmente, también hace mención de las “proteínas” alternativas diciendo que el 2023 será un año de consolidación de las mismas, aunque el crecimiento estelar que han tenido de los productos a base de plantas está en un compás de espera, y los inversores están cambiando el enfoque.
Los costos de los insumos influyen en la competitividad
El alivio del coste de alimentación será raro

THOMAS NORTON
XXVI Congreso Mundial de Avicultura. París, agosto 2022
La agricultura de precisión es un enfoque para el diseño y control de las operaciones agrícolas y se ha aplicado en gran medida en los sectores de producción de los cultivos. Se considera que forma parte del manejo de las granjas y se centra específicamente en el control de los insumos basado en el monitoreo intensivo del proceso de los cultivos.
El objetivo es maximizar la productividad espaciotemporal del cultivo dadas las limitaciones con las que se enfrenta la agricultura moderna y bajo la gobernanza de un modelo económico holístico de la granja. De esta manera, se optimiza la eficiencia de los recursos, mientras que el potencial genético se puede realizar mejor.
En el campo de la producción ganadera, la investigación y el desarrollo de la agricultura de precisión (PLF) está siendo
impulsado por demandas similares observadas en los sectors de producción de cultivos, pero con la complejidad adicional de defender el bienestar animal como parte de una producción animal sostenible y productiva.

En los últimos años hemos visto un notable desarrollo en tecnologías para monitorear diversos indicadores de productividad, salud y bienestar animal a nivel individual y de grupo. La PLF ha surgido con el objetivo de vincular estos indicadores con tecnologías como sensores, software de análisis y visualización de datos y la robótica, de una forma que permita a los ganaderos gestionar de manera sostenible sus prácticas agrícolas. Al hacer esto, no hay duda de que otras partes interesadas en la cadena de valor también
pueden estar implicadas de manera positiva. Por ejemplo, la genética animal y los fabricantes de piensos pueden utilizar la información proveniente de estas tecnologías para mejorar los insumos para el sistema agrícola y ayudar a los productores a equilibrar el objetivo de la eficiencia, el bienestar y el impacto ambiental.
Aquí presentamos los principios básicos que sustentan la innovación de los sistemas de detección, el manejo de grandes cantidades de datos generados para el monitoreo de los animales y las posibles tecnologías que pueden abordar las necesidades del sector avícola en el futuro. También se presenta la aparición de sistemas robóticos que tienen el potencial de apoyar mejor a los avicultores de manera espacio-temporal.
El principio básico de los sistemas PLF es medir continuamente las respuestas de los animales de forma directa en vez de indirectamente del entorno que los rodea. Mejorar los ojos, los oídos y tal vez la nariz de los agricultores mediante el
monitoreo de los animales solo es posible de forma directa y totalmente automatizada, 7 días por semana, las 24 horas al día y 3600 segundos por hora. Al acumular estas respuestas se puede conocer una información interesante sobre el bienestar y la salud
del animal. Las tecnologías modernas, como el control ambiental y los programas financieros, ya miden una serie de parámetros en la granja, aunque la tecnología PLF permite que el animal sea la preocupación central.
El criterio clave para medir las respuestas de los animales es realizarlo de una manera firme y rentable. Esta es la razón por la que los sensores como cámaras y micrófonos son muy útiles pues como no hay un contacto físico con el animal no hay riesgo de influir en él. El costo para el agricultor también puede ser mínimo ya que muchos animales pueden ser monitoreados usando un pequeño número de sensores. Por otro lado, los sensores portátiles también brindan
la oportunidad única de estar conectados al animal, de modo que ningún comportamiento pase desapercibido. Además, si bien la aplicación de sensores y los sistemas de TIC (*) que la acompañan es una parte central de la ganadería de precisión (PLF), todavía hay más espacio para avanzar en robótica para eliminar las tareas monótonas simples de las manos del productor avícola. Al hacerlo, éste puede centrarse en otros aspectos

de su negocio, así como en mejorar los estándares de manejo de sus animales. Además, a través de la adopción de robots, el papel del productor puede cambiar ya que los robots dan la oportunidad de que su tiempo se use de manera diferente.
Esta revisión cubrirá brevemente las tecnologías de PLF, incluido el potencial de la robótica móvil para monitorear y administrar las instalaciones avícolas.
Se ha demostrado que el monitoreo continuo basado en cámaras del comportamiento de las manadas de pollos es un medio para detectar problemas diarios en las grandes manadas. Por ejemplo, el comportamiento anormal de las manadas de pollos se puede detectar utilizando algoritmos para medir el patrón de ocupación de los mismos con un pronóstico de lo que debería ser en diferentes momentos del día. Y también se ha demostraron que, en base a esta actividad y el monitoreo de la ocupación, existe una correlación entre las desviaciones de la misma y dos importantes problemas refrentes al bienestar, las lesiones plantares y las quemaduras de tarsos porque ello indica que las aves que tienden a agruparse durante un período de tiempos más largo se enfrentan un mayor riesgo de infección en las mismas. Esto se corresponde con una observación previa de que los pollos menos activos criados sobre una cama en mal estado pueden empeorar este tipo de lesión.
Pero aún se ha trabajado más sobre el empleo de otras variables derivadas de imágenes, como el flujo óptico, para rastrear las desviaciones del comportamiento de las manadas, lo que implica características de los patrones generales de flujo del movimiento de las aves, que se ha demostrado que están correlacionados con los indicadores de salud y bienestar.
Fig. 2 Aplicaciones diferentes de la misma solución basada en cámaras para el monitoreo del comportamiento de las aves. A la izquierda, herramienta para el análisis de la calidad del sueño de las gallinas y a la derecha, monitoreo del bienestar de los pollos.
La misma tecnología de cámara se puede aplicar para el monitoreo del comportamiento de las gallinas al haberse desarrollado recientemente una herramienta basada en ello para ayudar a estimar el nivel de infestación del ácaro rojo (PRM) de las aves, en las naves. Este ácaro representa una amenaza para la producción de huevos y su control es muy difícil ya que tiende a esconderse en las grietas de los gallineros durante el día, aunque es activo durante la noche para ir a alimentarse de la sangre de las gallinas
Debido a que el PRM infesta el plumaje de las aves, al irritar a las gallinas éstas muestran un comportamiento inquieto durante la oscuridad, lo que se ha podido identificar para luego relacionarlo a través de algoritmos de visión por computadora. Como se ve en la figura 2, se crea un mapa de calor bidimensional y, a su vez, se utiliza para extraer una característica que refleja la calidad del sueño de las aves, pudiendo utilizarse luego los resultados como una herramienta de monitoreo que indica los niveles de infestación del parásito.

Aunque se ha trabajado mucho para mejorar el rendimiento de las patas de los broilers, ello ocupa bastante tiempo y pese a que la genética está mejorando, todavía se necesita mucho trabajo para manejar el problema en las granjas. Una solución es a través de la alimentación para que el crecimiento compensatorio pueda controlarse activamente para que el peso de las patas de los pollos aumente de acuerdo con su desarrollo físico.
En comparación con la alimentación ad libitum podría ser interesante controlar activamente la variación del crecimiento (el peso en función del tiempo) de los pollos de una forma más económica para reducir la mortalidad y los problemas de patas. Un aspecto clave de tal proceso de control es el modelo de trayectoria de crecimiento, que se puede construir cuando se conoce la ingesta precisa de pienso por ave así como el peso de los pollos.
La relación dinámica entre el input de la alimentación y el output del proceso se puede determinar y utilizar para predecir la respuesta dinámica del peso al suministro de pienso. Y sobre la base de esta predicción, se puede calcular la cantidad de pienso que se requiere para obtener una determinada respuesta de peso. Los trabajos de Aerts y col. (2003) han demostrado que un controlador basado en modelos en tiempo real de este tipo es capaz de realizar una trayectoria deseada de crecimiento en los broilers.
ECO Unit, un intercambiador de calor que crea un clima saludable con una ventilación mínima.

• Mejor yacija y mejor Índice de conversión
• Niveles de amoníaco un 35% más bajos
• Hace circular hasta 30.000 m3 de aire por hora

• Ratios más altos de rendimiento vs intercambiadores de calor más pequeños

Financiación exible




Sin inversión inicial
Para más información
Vencomatic Ibérica S.L.
Tel. : 977 331 908 | info@vencomatic.es
C/ Pintor Fuster, 21 | 43205 REUS (Tarragona)
¡Pídelo ahora e instalalo antes del invierno!
Un medio para manejar la alta incidencia de debilidad de las patas en los pollos actuales también se puede hacer favoreciendo una mayor actividad durante el crecimiento. Como todos los animales, los pollos están influenciados por su microclima por lo que un estimulador potencial de su actividad es cambiando su entorno. Esto, por supuesto, no es la única o la mejor opción de estimulación.
En un estudio de Youssef y col. (2015) se desarrolló un controlador que es capaz de manipular, espacialmente, el nivel de actividad de los pollos dentro de una cámara ventilada prestando atención a la mayoría de las restricciones (por ejemplo, la limitación de los sistemas de calefacción y ventilación) y a los objetivos de control (por ejemplo, evitar los estrés por calor / frío al limitar las acciones de control dentro de las zonas termoneutrales de las aves).
La figura 3 muestra un ejemplo de las respuestas conductuales de las aves dentro de la cámara a un aumento escalonado en la temperatura de entrada de 25 o C (la potencia del calefactor es mínima) a 45 o C a un nivel de ventilación constante de 4,5 m3/h. A baja temperatura ambiente (25 o C) las aves ocuparon las zonas más cercanas a la fuente de calor, tendían a acercarse entre ellas y mostraban una baja actividad general en la cámara. Durante la fase transitoria, cuando la temperatura ambiente comenzó a aumentar, los pollos comenzaron a mostrar un aumento en su actividad general y se separaron entre ellos. En el estado estacionario, la temperatura del aire ambiente en las zonas cercanas a la fuente de calefacción había alcanzado un nivel alto (>41 o C) haciendo que los pollos se alejaran de ellas (con una constante de tiempo promedio de 0,25 a 4,2 min) y entre sí. Esta investigación muestra que puede ser posible controlar la actividad.

La robótica ya está presente en el sector de la producción avícola desde hace muchos años. Un ejemplo de un proceso robótico en el sector actual de la producción huevera en baterías es el empleo de cintas transportadoras integradas para la recogida y transportar de los huevos a la sala de clasificación y embalaje.
Además, en los últimos años hemos visto la introducción de vehículos autónomos que son capaces de moverse por todo el gallinero, monitorear el medio ambiente y realizar una serie de tareas, con tienen el potencial de ahorrar tiempo al productor.
Algunos ejemplos son: Monitoreo de la calidad de la yacija para evitar que en caso de estar muy húmeda
ello pueda comprometer la salud y el bienestar de las aves. La oportunidad para un sistema robótico es muestrear su calidad para acondicionarla cuando se detectan costras o una saturación de humedad.
Monitoreo de comportamiento anormal: de los pollos, como importante indicador del bienestar, que actualmente se evalúa a través de la "puntuación de la marcha" mediante observación humana. La oportunidad para la robótica es monitorear el movimiento de las aves para cuantificar su capacidad para caminar mediante la evaluación de la interacción del robot con el pollo

Detección de los pollos muertos, una tarea que debe realizarse a diario y no es agradable para ningún criador. Las tecnologías robóticas ahora se están llevando al mercado con la aplicación de la detección de aves muertas en mente.
Actualmente hay un pequeño número de soluciones robóticas, cada una de las cuales proporciona un conjunto bastante específico de aplicaciones con su propia y única propuesta de valor. En el futuro, la perspectiva de plataformas robóticas modulares, como la conceptualizada en la figura 4, que permita realizar diferentes aplicaciones con la misma unidad podría generar oportunidades interesantes para el avicultor en el futuro.
El desarrollo de PLF a partir de un concepto hacia una oportunidad viable para los avicultores ya ha comenzado. Los sistemas PLF están disponibles en los productos y se están poniendo en funcionamiento en las granjas comerciales. El reto clave no es la innovación de la tecnología, sino el descubrir cómo estas tecnologías pueden crear valor para los animales y los agricultores. La ventaja fundamental es que los sistemas PLF están monitoreando

continuamente y los 7 días de la semana y las 24 horas del día. Esto es mucho más de lo que cualquier agricultor u observador humano puede esperar hacer sin la ayuda de la tecnología. Otras formas en que los sistemas PLF pueden crear valor incluyen el ahorro de tiempo de trabajo y de tiempo en la detección de problemas, favorecer un menor estrés para los productores, resolver inmediatamente los problemas en el lugar en vez de más tarde, ofrecer un reconocimiento social al
criador, cuantificar lo que sucede a los animales, etc.
Si bien es evidente que existen oportunidades para las aplicaciones basadas en sensores y datos, debe realizarse una colaboración multidisciplinaria y multisectorial para que estos sistemas se conviertan en herramientas de apoyo útiles en el campo. Lo más importante es que las necesidades del productor solo pueden representarse plenamente si el mismo forma parte del proceso de innovación.
“One Health” es un enfoque colaborativo y polidisciplinario que actúa a nivel local y global con el objetivo de lograr una salud óptima para los animales, las personas y el medio ambiente. “One Health” se ha vuelto más importante en los últimos años porque muchas interacciones entre animales, personas y el medio ambiente han cambiado.
SUSAN LAMONT
La población humana está creciendo y expandiéndose a nuevas áreas geográficas. Por lo tanto, hay más oportunidades para el contacto cercano entre las aves, el ganado, los animales silvestres, las mascotas y las personas, lo que brinda más oportunidades para que las enfermedades pasen entre los animales y las personas. El aumento de la población humana y las economías en crecimiento generan la necesidad y el deseo de más alimentos de origen animal en la dieta humana. Se están produciendo cambios en el clima y el uso de la tierra, incluida la expansión de las prácticas agrícolas intensivas y el establecimiento de la producción animal en nuevas áreas, lo que puede aumentar la huella ambiental de la producción animal.
Las interrupciones en las condiciones ambientales y los hábitats también pueden proporcionar nuevas oportunidades para que las enfermedades pasen a los animales domésticos y potencialmente a los seres humanos.
Para satisfacer las preferencias de los consumidores en algunas regiones, las aves se crían en entornos más extensos que pueden permitir una mayor exposición a las aves silvestres. El movimiento de personas, animales y productos de origen animal ha aumentado debido a los viajes entre países y al comercio mundial y, por lo tanto, las enfermedades pueden propagarse rápidamente por todo el mundo.
LOS TEMAS IMPORTANTES DE “ONE HEALTH” INCLUYEN ENFERMEDADES ZOONÓTICAS, RESISTENCIA A LOS ANTIMICROBIANOS, SEGURIDAD ALIMENTARIA, ENFERMEDADES TRANSMITIDAS POR VECTORES, LA HUELLA AMBIENTAL Y OTROS RETOS DE SALUD COMPARTIDOS POR LAS PERSONAS, LOS ANIMALES Y EL MEDIO AMBIENTE.
La sostenibilidad a largo plazo de la producción avícola es crucial y consta de muchas facetas diferentes, además de la sostenibilidad económica, ambiental y social. Broom (2018) propone una definición muy amplia de insostenibilidad como "cualquier efecto que el público en general considere inaceptable hace que un sistema sea insostenible, por ejemplo, un uso ineficiente de los recursos mundiales, unos efectos adversos en la salud humana, unos impactos negativos en el bienestar animal, unos efectos ambientales dañinos, una modificación genética inaceptable, no ser "comercio justo" o un daño a las comunidades rurales".
Como animales terrestres productores de alimentos más eficientes, las aves domésticas proporcionan a los seres humanos proteínas y micronutrientes económicos y de alta calidad con menos impacto en el medio ambiente. Su pequeño tamaño los hace susceptibles de ser criadas en muchos entornos. Dos análisis de cambios a largo plazo en los sectores del huevo y del broiler demuestran la forma en que la producción avícola ha reducido su huella ambiental en varias de las últimas décadas.
Pelletier y col. (2014) han realizado una evaluación del ciclo de vida de la huella ambiental de la producción de huevos en los Estados Unidos, comparando 2010 con 1960, lo que ha revelado un gran progreso por parte de este sector en la misma durante ese período: con una producción de huevos un 30% más alta en 2010 que en 1960, la huella fue:
63 % menores emisiones de gases de efecto invernadero, 54 % menores emisiones acidificantes, 65 % menores emisiones eutrofizantes y 13 % menor demanda general de energía.
De estas reducciones en la huella ambiental, el 28-42% se estimó como debido a la mejora del rendimiento de las aves, el 30-44% a los cambios en la composición del pienso y el 27-30% al resto, como la mejora de la eficiencia en el transporte, el suministro de energía, la producción de fertilizantes y la producción de piensos. Los tres factores principales que influyen en el impacto ambiental se identificaron como la eficiencia del pienso, la composición del mismo y la gestión de las deyecciones. Estos factores, por lo tanto, son objetivos de alto interés para la mejora continua en la reducción de la huella ambiental.
Para determinar el efecto de la selección genética en la eficiencia, el crecimiento y el rendimiento de los broilers, Zuidhof y col. (2014) compararon el rendimiento de dos tipos genéticos de pollos para carne que no fueron seleccionadas desde 1957 y 1978, con otra genética comercial de 2005, la Ross 308. La selección genética
durante el período de casi 50 años dio como resultado unas aves con un aumento del 400% en el crecimiento y una reducción del 50% en el índice relación de conversión, al mismo tiempo que una disminución de la proporción de grasa abdominal y un considerable aumento de los músculos pectorales mayores y menores.
El resultado combinado de estos cambios fue una reducción de la mitad del pienso necesario para producir carne de pollo, contribuyendo así a un sector sustancialmente más eficiente y una menor huella ambiental por unidad de alimentos producidos para el ser humano.
Los animales, incluidas las aves, pueden afectar directamente el medio ambiente circundante, incluida la calidad de las cuencas hidrográficas. Esto puede ocurrir por la escorrentía de aves criadas en pastizales o por la aplicación de estiércol de operaciones a gran escala en tierras agrícolas. El exceso de nutrientes, especialmente el fósforo y los microorganismos pueden contaminar las fuentes de agua dulce e impactar el agua utilizada para la bebida y otros usos y, por lo tanto, deben gestionarse adecuadamente (Rothrock y col. 2019).
 ENFOQUES PLURIDISCIPLINARIOS PARA ALCANZAR LOS OBJETIVOS DE “UNA SOLA SALUD"
ENFOQUES PLURIDISCIPLINARIOS PARA ALCANZAR LOS OBJETIVOS DE “UNA SOLA SALUD"
Las enfermedades zoonóticas son aquellas compartidas entre animales y los seres humanos. Se estima que:
causan 2.500 millones de casos humanos de enfermedades y 2,7 millones de muertes anuales en el mundo, que más del 60% de las enfermedades infecciosas conocidas en los seres humanos se adquieren potencialmente de animales y que el 75% de las enfermedades infecciosas nuevas o emergentes en los seres humanos provienen de animales.
Las enfermedades transmitidas por vectores están aumentando debido a las temperaturas más cálidas y la expansión de los hábitats para mosquitos y garrapatas. Las aves proporcionan alimentos nutritivos para los seres humanos, aunque, tal como cualquier animal, pueden albergar una variedad de microorganismos, incluidos patógenos de seguridad alimentaria como Campylobacter spp., Salmonella spp. y Clostridium perfringens.
Aunque los procedimientos adecuados de preparación de los alimentos eliminan estos patógenos, se estima que un millón de personas enferman anualmente en EE.UU. por comer aves contaminadas (CDC, 2022). Las enfermedades transmitidas por los alimentos son problemas de salud importantes tanto en los
países desarrollados como en los que están en vías desarrollo, con una carga mucho mayor en estos, por tener menos acceso a unas instalaciones adecuadas de almacenamiento, higiene y preparación de alimentos y, potencialmente, un contacto más cercano entre los humanos y animales (Abebe y col. 2020).
La información sobre las fuentes prevalentes de patógenos indica las estrategias de control efectivas para reducir la transmisión de los productos avícolas a los seres humanos. Por ejemplo, la identificación de los huevos como fuente de un gran número de casos de salmonelosis en Dinamarca fue seguida por estudios de referencia de la Unión Europea sobre gallinas y luego por la implementación de programas de control en los sistemas de producción que se tradujeron en una reducción sustancial de
Salmonella spp. en las granjas de puesta (Boqvist y col. 2018). Esto demuestra el enfoque holístico de “One Health” de identificar un problema, recopilar los datos relevantes, comunicarse de manera efectiva y hacer políticas adecuadas para modificar las prácticas y, por lo tanto, reducir con éxito las zoonosis.
La influenza aviar (IA) es un ejemplo del concepto central de “One Health” de interrelación del medio ambiente, los animales y los seres humanos. Los virus de la IA se encuentran entre los más preocupantes que afectan a la salud humana y animal, en este último caso a una amplia variedad de especies, incluido el reservorio original de las aves acuáticas silvestres y las aves domésticas, así como muchas especies de mamíferos, evolucionando y adaptándose a nuevos huéspedes de especies y exhibiendo una alta frecuencia de transmisión entre ellas (Short y col. 2015).
Los subtipos H5 y H7 del virus de la IA de baja patogenicidad (LPAI) pueden evolucionar a una IA de alta patogenicidad (HPAI) en aves terrestres en las que los virus causan una infección sistémica y mortal. La HPAI evolucionada puede volver a cruzar las barreras de las especies y transmitirse a otras especies de aves y mamíferos, incluidos los humanos.
La aparición de la influenza
aviar H5N1 y H7N9 en China ocurrió en el momento de la intensificación de la producción avícola en áreas con agricultura de humedales y un hábitat de aves acuáticas silvestres, brindando una oportunidad para una exposición extensa al reservorio de estas últimas a los virus. (Gilbert y col. 2017). Los mercados de aves vivas apoyaron la propagación y persistencia de la IA aviar, así como la exposición humana.

Sin embargo, la aparición de la IAAP también se ha producido en países con altos estándares de bioseguridad, pero generalmente también en áreas de una producción avícola intensiva. Las aves acuáticas silvestres suelen ser portadoras asintomáticas del virus de la IA y, por lo tanto, pueden distribuirlo ampliamente durante su extensa migración. La prevención del contacto entre unas aves y otras y la transmisión del virus de las acuáticas silvestres a las fuentes de agua y las instalaciones utilizadas por las aves domésticas reducirá el riesgo de propagar el virus (Elmberg y col. 2015).
DEBIDO A LA COMPLEJIDAD DE LAS MEDIDAS DE CONTROL, INCLUIDA LA VACUNACIÓN CONTRA LA GRIPE HUMANA, EL EQUIPO DE PROTECCIÓN PERSONAL, EL MANEJO DE LAS DEYECCIONES Y LAS PRÁCTICAS DE BIOSEGURIDAD, SE NECESITA UN ENFOQUE MÚLTIPLE PARA REDUCIR LA TRANSMISIÓN DE LA IA A LAS AVES Y LOS HUMANOS (MOORE Y COL. 2021).
Un problema importante dentro de “One Health” es el desarrollo y la propagación de microbios resistentes a los antibióticos. Si una población microbiana está expuesta a antimicrobianos en su organismo huésped o su entorno, la porción susceptible de la misma muere y el pequeño porcentaje que es genéticamente resistente se expande.
En la producción animal los antimicrobianos se utilizan terapéuticamente para tratar individualmente a los animales enfermos. Sin embargo, para mayor eficiencia, a menudo se administran como profilaxis a través del agua o el pienso a grupos enteros de aves (a animales sanos en riesgo de infección), o bien como metafilaxis (a animales sanos en el mismo grupo que los animales enfermos) (Collignon y Ewen, 2019).
Las bacterias ambientales, al ser los organismos más abundantes, sirven como fuentes de genes AMR que pueden incorporarse a patógenos de personas y animales. Este es un fenómeno natural. Sin embargo, se acelera al depositar microbios con genes AMR en el medio ambiente a partir de desechos de aves, otros animales y humanos y residuos de antibióticos de la industria farmacéutica y hospitales y granjas intensivas (Robinson y col. 2016).
Los patógenos resistentes a los antimicrobianos pueden propagarse rápidamente a través de las poblaciones animales y humanas y el medio ambiente, lo que dificulta el tratamiento de futuras infecciones en animales y personas.
Se necesita una investigación y una acción multidisciplinaria basada en la salud para detener el aumento de la AMR (White y Hughes, 2019) que, para tener éxito, debe ser sensible al papel que desempeñan las aves y otras especies de animales como fuentes de alimentos en los medios de vida de todo el mundo.
Lograr los objetivos de “One Health” de mantener y mejorar la salud de los animales, las personas y su entorno depende del trabajo colaborativo de unos equipos que representen disciplinas diversas y complementarias, incluidas la nutrición, la fisiología, la genética, la medicina veterinaria y humana, las ciencias ambientales, la ingeniería agrícola, las comunicaciones y muchas más. Además, se necesita la participación de los responsables de la formulación de políticas, la legislación y el público. Debido a que las especies avícolas son altamente eficientes en la producción de alimentos, pueden desempeñar un papel importante en la seguridad alimentaria mundial y también en el apoyo a "One Health".
He estado aprendiendo sobre la coccidiosis desde la escuela de posgrado, en 1990. De hecho, mi tesis de maestría fue sobre la coccidiosis en los broilers, con un texto de 150 páginas sobre ello.

En los siguientes 30 años he lidiado mucho con la coccidiosis, y ha sido un viaje interesante. Una cosa es segura: siempre hay más que aprender y mantenerse al día con esta ubicua enfermedad sigue siendo un reto.
Como la mayoría de los veterinarios de campo he utilizado ionóforos, que debilitan las paredes celulares de los coccidios, afectando así directamente al parásito. Y aunque es de esperar algún brote, éste no es grave. La exposición limitada permite que los intestinos de las aves interactúen con el parásito, lo que inicia su inmunidad.
En contraste, los coccidiostos no ionóforos operan dentro de las células del parásito, mientras que los coccidios mismos se replican dentro del tejido huésped. Este tipo de coccidiostatos, si es eficaz, mantiene las infecciones en niveles lo suficientemente bajos como para prevenir una respuesta inmunitaria significativa. En términos generales, los ionóforos tienden a mantener la eficacia durante períodos de tiempo más largos en comparación con los coccidiostatos no ionóforos, ya que inducen inmunidad, pero siempre hay excepciones a esta regla.
PHILIP
SANDERSON FARMS,
Durante mis primeros años en la producción, se utilizaba una gama de coccidiostatos y se rotaban según la época del año en un intento de reducir la resistencia, mantener la eficacia del producto y minimizar el parasitismo de la manada. Admitiré fácilmente que, a pesar del monitoreo cuidadoso del estado de salud de la manada, hice algunos cambios en el tiempo al pensar que eran buenos planes para el control de la coccidiosis, aunque terminando por desechar un plan que no estaba funcionando, bien por haber tenido un brote de coccidiosis clínica o por unas malas conversiones del pienso.
También he utilizado vacunas contra la coccidiosis, conteniendo poblaciones de varias especies de Eimeria en dosis formuladas que, en realidad, originan una infección limitada para que los pollos desarrollen inmunidad, pero sin enfermedad clínica. En Estados Unidos hay varias vacunas comerciales disponibles contra la coccidiosis y todas ellas contienen al menos las tres especies de Eimeria que más a menudo originan coccidiosis en los broilers: E. acervulina, E. maxima y E. tenella.
Las vacunas contra la coccidiosis se administran directamente en el huevo embrionado antes de la eclosión o se rocían sobre los polluelos el día de la eclosión. Independientemente de la tecnología de aplicación, los pollitos deben consumir ooquistes esporulados para que cualquiera de las vacunas sea eficaz. El simple hecho de ver el tinte agregado a la vacuna en la espalda de los pollitos o en la boca cuando se rocía la vacuna no significa que cada pollito recibió una dosis efectiva, aunque la mayoría de las vacunas pueden reclamar una absorción de más del 90%.
Mi uso de vacunas contra la coccidiosis generalmente se ha limitado a los meses de verano debido al manejo necesario de la manada. Las aves jóvenes necesitan dispersarse por toda la nave antes de que se acumulen grandes niveles de ooquistes en la zona de crianza, lo que es más fácil de hacer en verano que en invierno.
Durante varios años he intentado utilizar vacunas contra la coccidiosis sin coccidiostatos, pero he descubierto que la salud de la manada no era tan buena como cuando la vacunación era seguida por un coccidiostato, aunque no antes de los 14 días de edad, ya que con ello se corre el riesgo de matar los ooquistes vacunales que estimulan la inmunidad.
También descubrí que, después de la vacunación, el 3-nitro era tan efectivo como el uso de un coccidiostato en el pienso. Cuando el 3-nitro se eliminó del mercado, fue una lucha encontrar un reemplazante bastante efectivo, aunque varios coccidiostatos en el pienso estuvieron cerca de ello.
Hoy en día, la combinación de la vacunación seguida de varios coccidiostatos, a menudo llamados un programa de “bioshuttle”, sigue siendo el programa favorito entre los productores de broilers convencionales. Curiosamente, he encontrado que unas dosis más altas de ionóforos son necesarias para lograr el mismo grado de control de la coccidiosis que las dosis más bajas con el 3-nitro. No sé por qué, pero tal vez el 3-nitro proporcionó un apoyo adicional para el control de la coccidiosis que no apreciamos hasta que se retiró del mercado. Para recuperar la salud de la manada a los niveles anteriores, ahora parece que tanto la vacunación contra la coccidiosis como las dosis más altas de ionóforos son necesarias. Eso se basa en las puntuaciones de lesiones intestinales y el rendimiento de las manadas.
Teóricamente, las vacunas contra la coccidiosis inician infecciones subclínicas que inducen inmunidad, mientras que los coccidiostatos en el pienso tratan a las aves en la manada que no se vacunaron de recién nacidas. Una dosis efectiva de cualquier especie de Eimeria originará en un aumento del eliminación de ooquistes. Si se deja de vacunar un pollito de recién
La época del año afecta el momento de la vacuna
nacido, la próxima exposición a la coccidiosis puede ser 10 o incluso 100 veces mayor si el mismo consume las heces de los compañeros de la manada que fueron vacunados adecuadamente.
Los pollos más jóvenes parecen más resistentes a una exposición coccidiana que los más viejos, tal vez debido a su superficie limitada de mucosa intestinal para la proliferación de los parásitos. Más adelante en el crecimiento, una dosis más alta de ooquistes coccidiales y su mayor configuración intestinal hace que los compañeros de la manada tengan un mayor riesgo de coccidiosis clínica que los que fueron vacunados al nacer.. El uso de un coccidiostato, particularmente un ionóforo, ayuda a limitar el daño a los pollos que están expuestos más adelante en la vida a recuentos elevados de ooquistes.
Mi recomendación actual para el control de la coccidiosis es utilizar la gama de coccidiostatos disponibles. A efectos prácticos esto significa el uso de una vacuna contra la coccidiosis aplicada in ovo o nebulizada sobre los pollitos recién nacidos seguida de un coccidiostato en el pienso. Las vacunas contra la coccidiosis deben usarse en la dosis recomendada para obtener resultados óptimos. Los coccidiostatos en el pienso deben usarse a la dosis efectiva más baja, pero a unas dosis variables con aumentos y disminuciones según sea necesario en base al monitoreo de la salud del manada.

En nuestro caso hemos tenido éxito utilizando programas de “bioshuttle” en diferentes zonas y épocas del año, incluso durante todo el mismo, y no hemos visto ningún problema con resistencias.
La coccidiosis es posiblemente el patógeno más caro para la producción comercial de broilers ya que es una enfermedad intestinal que afecta directamente la utilización del pienso y la alimentación es la principal partida económica de la misma. Mirando hacia atrás a lo largo de los años, el principal cambio que afecta el control de la coccidiosis es la pérdida de herramientas efectivas. Para los sistemas convencionales fue la pérdida de 3-nitro, mientras que para los sistemas sin antibióticos, es la prohibición de usar ionóforos, ya que la FDA los considera antibióticos.
Aparte de esto, no ha habido muchos cambios ya que ha habido una escasez de nuevos coccidiostatos. Será interesante ver en las próximas décadas si hay algún cambio significativo en la forma en que se maneja la coccidiosis.
MANTENIMIENTO
WILMER J. PACHECO
Poultry Sci. 100 (E-Suppl. 1), Annual Meeting Online
Las mejoras que se han ido produciendo a lo largo de los años tanto en la selección genética de las aves como en el campo de la nutrición han hecho que los actuales broilers alcancen los pesos comerciales que exigen los mercados en unos períodos de tiempo cada vez más cortos, al mismo tiempo que con una menor cantidad de pienso en relación con su ganancia en carne.

Y debido a que el pienso que reciben los pollos constituye la única fuente de suministro de los nutrientes que requiere, es esencial que estos reciban los mismos en cada bocado que ingieran.
Por otra parte, las industrias de la alimentación han evolucionado a lo largo de los años desde unos molinos que se movían con la fuerza del agua hasta unas fábricas de piensos totalmente automatizadas. Y aunque los principios de la fabricación de piensos han permanecido constantes, actualmente se dispone de numerosas nuevas tecnologías.
de la migración de calor y humedad hacia el centro de las partículas y aumentar la calidad de los granulados. Sin embargo, entre la temperatura a alcanzar y el tiempo de retención debe mantenerse un equilibrio para proteger tanto la estabilidad de los nutrientes termolábiles como de las enzimas exógenas. Y después del acondicionamiento la masa del pienso se envía a la matriz de la granuladora, provista de múltiples orificios, que es la encargada de la formación de los múltiples enlaces entre las partículas húmedas y la gelatinización de la superficie del granulado, lo que contribuye a su durabilidad.
Las estrategias de manejo deben ajustarse para cada situación en particular. Por ejemplo, si la durabilidad del pienso granulado es superior a un 90 % pero los empleados deben trabajar más, pero sin disponer de tiempo para el mantenimiento del equipo, un aumento de un 0,25 % de la cantidad de grasa en la mezcladora o una reducción de un 10 % de los orificios de la matriz de la granuladora puede aumentar el ritmo de producción. Y, por lo contrario, si la calidad de los gránulos es marginal pero la producción va contrarreloj por estar cambiando continuamente en los tipos de piensos fabricados una reducción dl nivel d grasa puede aumentar la calidad del granulado.
A su vez, la presencia de unas partículas gruesas en la microestructura de los piensos granulados aumenta un peristaltismo inverso, la digestibilidad de los nutrientes y la eficiencia alimenticia de las aves.

Entre las técnicas empleadas en la fabricación de piensos el acondicionamiento ha sido diseñado con el fin de aumentar la eficiencia
Luego, durante el proceso de enfriado del granulado, se forman enlaces sólidos entre las partículas del pienso y los componentes solubles son recristalizados. Además, es importante comprender la relación entre el flujo de aire y el tiempo de retención con el fin de controlar la humedad y la temperatura en el pienso acabado. En general, esto se hace con la finalidad de mantener un equilibrio entre la producción de la granuladora y la calidad de los gránulos salidos de ella, lo que se consigue tanto con un adecuado mantenimiento del equipo como con en entrenamiento de los operarios que lo manejan.
En general, los cambios en el ritmo de producción justifican unas modificaciones en las estrategias del enfriado del granulado, así como en la evaluación de la calidad del pienso acabado. Si el mismo aumenta, también debe hacerse con el tiempo en la enfriadora con el fin de mantener un tiempo de retención comparable.
Una de ellas es el empleo de la variable frecuencia con la que se suele modificar el tamaño de las partículas del maíz mediante el ajuste de la velocidad en los molinos de martillos.
En resumen, es sumamente importante mantener un equilibrio entre los objetivos de la producción del pienso granulado, la calidad del mismo y el rendimiento de los broilers.

RAFAEL LERA
Hendrix Genetics, 7-11-2022
A pesar de la mejora permanente de los resultados productivos de las ponedoras que se puede evidenciar en diferentes condiciones de alojamiento y en todas las regiones del mundo, gracias a la selección genética y a los avances en nutrición, manejo y prevención de enfermedades, el prolapso sigue siendo una causa recurrente de preocupación para los productores avícolas.
La aparición de prolapso en gallinas ponedoras, bajo ciertas circunstancias, puede convertirse en una de las principales causas de mortalidad, con el consiguiente impacto negativo en el bienestar de las aves y en los resultados productivos de los lotes.
En este artículo revisaremos las condiciones que contribuyen fundamentalmente a la presentación del prolapso, con énfasis en las diferentes estrategias de prevención. Efectivamente, y como vamos a describir, las principales causas están relacionadas con los problemas de manejo durante la crianza y el inicio de la puesta, lo que significa que no existe un tratamiento efectivo y, por lo tanto, es una condición muy difícil de controlar una vez que ha aparecido. En este caso, más que nunca, podemos afirmar que el mejor método de control es la prevención.
Un lote bien recriado, con buen peso corporal y uniforme es la base para prevenir el prolapso
En condiciones normales, en el momento de la oviposición, se produce una eversión momentánea de la parte inferior del oviducto a través de la cloaca, que rápidamente se revierte. El prolapso en las gallinas ponedoras se produce cuando parte del oviducto no se retrae a su posición normal y queda expuesto, fuera de la cloaca, después de que la gallina ponga un huevo.
En estas circunstancias, el tejido expuesto presenta un aspecto congestivo y puede llegar finalmente a necrosarse, originando mortalidad. La complicación más frecuente se deriva de que las otras gallinas se sentirán atraídas por ese tejido rosado y húmedo y pueden comenzar a picarlo, pudiendo desencadenarse un brote de canibalismo que repercutirá en un incremento significativo de la mortalidad.
Ambas condiciones, prolapso y picaje/canibalismo, se presentan frecuentemente asociadas, porque no solo el picaje puede ser la consecuencia del prolapso original, sino que, a la inversa, el picaje de cloaca puede ser la causa primaria, y las pequeñas lesiones producidas en el tejido del oviducto en el momento de la oviposición acaban dificultando que éste se retraiga a su posición normal, apareciendo secundariamente el prolapso.

El prolapso se considera un síndrome multifactorial, lo que quiere decir que, frecuentemente, no hay una sola causa, sino que es una combinación de diversos factores responsables de la aparición del problema. Los factores fundamentales están relacionados con el desarrollo de las aves durante la fase de recría, esencialmente el peso y la composición y estructura corporal (desarrollo esquelético).
Adicionalmente, las alteraciones hormonales, la enteritis, el sobrepeso de las aves, la edad de inicio de la postura, una estimulación lumínica demasiado temprana, las dietas desequilibradas, la producción de huevos de doble yema y todas aquellas condiciones que favorezcan la aparición de un comportamiento de picaje, juegan también un papel determinante en la presentación del prolapso.
El peso vivo y el desarrollo y estructura corporal están muy relacionados con la aparición del prolapso. Por un lado, las gallinas con bajo peso, es decir, aves que no han tenido un crecimiento adecuado durante las primeras semanas de recría, que es cuando se determina la estructura esquelética de las aves, tendrán una cavidad pélvica poco desarrollada, así como unos tejidos del aparato reproductor y una musculatura insuficientemente desarrollada para la puesta. Por otro lado, las gallinas con sobrepeso, con exceso de grasa acumulada, serán más propensas también a padecer prolapso ya que los tejidos implicados en la oviposición (el oviducto y la musculatura de la cloaca) tendrán menor elasticidad y tono, por lo que el oviducto tardará más en retraerse

tras poner un huevo. Y, por último, las gallinas demasiado pesadas en general pondrán huevos de mayor tamaño, un factor adicional de riesgo: a mayor tamaño de éstos, mayor probabilidad de una distensión excesiva de los tejidos de la cloaca y mayor riesgo de desarrollar prolapso.
Unas buenas condiciones de alojamiento y manejo durante las primeras semanas de la recría, garantizando el espacio disponible recomendado para un buen crecimiento, así como la disponibilidad suficiente de comederos y bebederos para evitar fenómenos de competencia que puedan afectar negativamente al crecimiento y a la uniformidad, son esenciales en la prevención del prolapso.
El resto de las condiciones que aseguren un buen arranque de las pollitas en cría, como son la utilización de un programa de iluminación decreciente lento, un alimento de inicio suficientemente concentrado y el mantenimiento de un ambiente confortable (temperatura, humedad relativa y ventilación), son también fundamentales para obtener el desarrollo adecuado. El objetivo es seguir en todo momento la curva de crecimiento referencia para la estirpe, teniendo siempre presente que el desarrollo de las diferentes estructuras corporales (esqueleto, musculatura, tracto gastrointestinal…) sigue una secuencia en el tiempo específica, y no es posible compensar más adelante un déficit de crecimiento de cualquiera de ellas.

Las alteraciones del estado hormonal de las gallinas ponedoras pueden dar lugar a la aparición de prolapsos. Se ha descubierto que los niveles bajos de estradiol en plasma están asociados a la aparición de prolapso. Los niveles reducidos de estradiol en plasma disminuyen la actividad de la prostaglandina sintetasa, lo que provoca una disminución del nivel de prostaglandina en el oviducto. La prostaglandina desempeña un papel importante en la actividad muscular del oviducto. Unos niveles de prostaglandina demasiado bajos afectan negativamente al funcionamiento de la musculatura lisa del oviducto, favoreciendo la aparición de prolapso.
No hay que olvidar que la regulación hormonal en las gallinas ponedoras se ve muy afectada por la fotoestimulación (estimulación lumínica): como se ha comentado en el apartado anterior, el efecto del periodo de cría es esencial, por lo que hay que tener en cuenta el manejo y el programa de alimentación e iluminación utilizado en recría cuando se investiga una manada con una prevalencia significativa de prolapso.


El picaje de cloaca, y el canibalismo derivado de este comportamiento, puede considerarse tanto una causa como una consecuencia del prolapso en las gallinas.

El picaje de la cloaca es una de las formas más extendidas y graves de picaje severo: cuando aparece esta alteración del comportamiento, el canibalismo puede propagarse rápidamente y causar una elevada mortalidad. Las gallinas se sienten atraídas por el aspecto del oviducto expuesto fuera de la cloaca tras la oviposición, húmedo y brillante: si una de las aves del lote comienza a picarlo, las otras harán lo mismo por su curiosidad y tendencia a la imitación. Las lesiones que se producen
Como resultado del tamaño excesivo de los huevos de doble yema se ejerce mucha presión sobre el útero y la musculatura de la cloaca en el momento de la oviposición. Estos tejidos, cuando se estiran demasiado se debilitan y aumenta la posibilidad de desarrollar prolapso, ya que a la gallina le resulta más difícil retraer el útero.
El manejo adecuado del estímulo lumínico, efectuándose a la edad adecuada y evitando estímulos demasiado agresivos, ya sea en el fotoperíodo o en intensidad, es el factor más determinante para evitar el exceso de huevos de doble yema. Por otra parte, la mejora genética también puede ayudar a la reducción de la incidencia de prolapso al seleccionarse activamente en contra de la aparición de huevos de doble yema.
como consecuencia del picoteo repetido y la presencia de sangre estimularán aún más este picaje severo, agravando el problema. Incluso las gallinas que han sido sometidas a un tratamiento o recorte del pico pueden herir gravemente a otros miembros del lote, ya que el oviducto expuesto es un tejido blando que sangra con facilidad. No obstante, en las regiones en que el tratamiento de picos está autorizado por la legislación vigente, el riesgo de picaje severo se reduce significativamente siempre que este tratamiento se efectúe de manera precisa y con un resultado uniforme.
Cuando las gallinas están alojadas en sistemas libres de jaula, ya sea en suelo o en aviarios, habrá un mayor riesgo de aparición de
picaje en aquellos lotes que produzcan una cantidad significativa de huevos fuera de los nidos, en el suelo o en el sistema. Asimismo, cuando hay un número insuficiente de nidos, cuando los nidos están demasiado iluminados o son de diseño inadecuado, al quedar la cloaca expuesta en el momento de poner el huevo en el suelo, es más probable que otro miembro de la manada se sienta atraído para picarla. Aunque el prolapso puede aparecer en todos los sistemas de alojamiento, el canibalismo a menudo aparece con mayor frecuencia e intensidad en aves alojadas en jaulas, al existir más interacción entre las gallinas alojadas en la jaula y menos posibilidades para las víctimas para escapar de la agresión.
Frecuentemente, la mayor incidencia de prolapsos se produce alrededor del pico de producción, un momento de alta demanda metabólica para las aves. Conforme avanza la edad de las gallinas, los huevos aumentan naturalmente de tamaño, pero conseguir que ese crecimiento de su peso sea más aplanado, como se ha logrado gracias a la genética en algunas estirpes, permitirá que la demanda metabólica que sufrirán las aves en lotes de mayor edad sea menor, lo que reducirá el riesgo de desarrollar prolapso.
GALLINAS PONEDORAS: REVISIÓN
Los principales factores nutricionales que hay que considerar en las fórmulas para ayudar a prevenir la aparición de prolapso son la energía, la proteína y los niveles de calcio y fósforo. Concretamente, la utilización de un alimento de pre-puesta adecuadamente formulado para las necesidades específicas de este periodo, breve pero esencial, ya que es el momento en que se establecen las reservas de calcio en el hueso medular, lo que contribuirá a reducir el riesgo de aparición de prolapso más adelante.
Hay que tener presente que el calcio desempeña un papel importante, no sólo para la formación de la cáscara del huevo y unos huesos fuertes y sanos, sino también para el buen funcionamiento de los músculos y el mantenimiento del tono muscular. La debilidad muscular puede dificultar y retrasar la retracción del oviducto tras la puesta, y consecuentemente puede
aparecer prolapso. El asegurar los aportes adecuados de calcio y fósforo en cada fase de la vida en función de la masa de huevo producida para garantizar el buen funcionamiento de los mecanismos de absorción/ depósito/excreción de calcio es otro factor clave pare reducir el riesgo de prolapso.
El exceso de grasa en la región abdominal también favorece la aparición de prolapsos: la presencia de demasiada grasa puede llegar a estrechar el paso del huevo, aumentando la presión que necesita la gallina para ponerlo y estirando y debilitando la musculatura implicada. Por lo tanto, una dieta equilibrada que permita el mantenimiento del peso corporal en el rango recomendado y que no favorezca la acumulación de grasa abdominal es clave. Es importante evitar fórmulas con un contenido en energía demasiado elevado, ya sea por aporte excesivo de carbohidratos, aceites o grasas.
La utilización de niveles muy altos de proteína también potencialmente supondrá un mayor riesgo de prolapso, al favorecer la producción de huevos de mayor tamaño. Sin embargo, el estimular mediante la nutrición la producción de huevos de más peso en los mercados que así lo demandan no debería ser demasiado preocupante siempre que se haga de forma gradual.
Por último, el papel de la fibra no debe subestimarse en relación con el comportamiento de las gallinas ponedoras y puede tener un impacto muy positivo en la salud intestinal, lo que a su vez repercute en un mejor comportamiento de las gallinas ponedoras, que mostrarán menor tendencia al picaje.

SERTEC
Naves prefabricadas para 3.000 ponedoras ecológicas (adecuadas también para camperas y aviarios)
El mejor precio en estructuras para gallineros pequeños y medianos. Diseño y cálculo de la estructura realizada integramente por nuestro equipo de ingeniería. Fabricación propia en España (Tarragona). 50 años construyendo naves ganaderas.

Disponibles SIN o CON montaje incluido. Garantía 10 años en proyectos “Llaves en mano”. Naves totalmente desmontables con certificado C.E. de conformidad del control de producción según norma EN. 1090. Anteproyectos gratuitos. Somos estructuristas al 100%.

“ECO-LAYERS 3.000”
Unas condiciones de intensidad luminosa excesiva estimularán la actividad de las aves y facilitarán que vean más fácilmente el oviducto expuesto tras la puesta de los huevos y les llame la atención, ya que son naturalmente curiosas.
El estímulo lumínico (fotoestimulación mediante la adición de horas suplementarias de luz) debe hacerse siempre en función del peso corporal y la uniformidad, nunca basado exclusivamente en la edad de las aves. Aunque es sobradamente conocido, siempre conviene recalcar la trascendencia que tiene controlar semanalmente el peso corporal durante el periodo de recría y asegurar que el crecimiento sigue los objetivos recomendados para la estirpe.
Un efecto importante de la luz es la alteración de la edad de aparición de la madurez sexual de las aves, y de la aparición de los primeros huevos. Es importante tener presente que no es la intensidad de la luz lo que afectará fundamentalmente a la edad de madurez sexual, sino el cambio en la duración del día percibido por las aves (las horas de luz). De nuevo, reiterar que la evolución del peso corporal durante la recría aporta mucha información sobre su nivel de desarrollo y composición corporal.
Las pollitas que reciben un estímulo lumínico antes de que el tracto reproductivo haya
madurado completamente serán candidatas a padecer problemas de prolapso más adelante en la fase de puesta. Los lotes de aves excesivamente precoces producirán huevos pequeños, pero indudablemente son más propensos la aparición de problemas de prolapso, como consecuencia de que las aves tendrán una estructura corporal pequeña y un tracto reproductivo no completamente desarrollado. Es esencial tener en cuenta la uniformidad de la manada: cuando la variabilidad en pesos es excesiva, al avicultor le resultará muy difícil tomar la decisión correcta respecto al momento de la fotoestimulación: si solo se tiene en cuenta el peso corporal

medio para las aves más ligeras puede ser demasiado temprano y eso repercutirá en mortalidad por prolapsos en la producción.
En el momento de la estimulación lumínica no es aconsejable que ésta sea demasiado agresiva, evitando incrementos demasiado amplios en duración o un aumento brusco de la intensidad, ya que provocarán una mayor incidencia de huevos de doble yema. Siempre es importante respetar las recomendaciones de las diferentes estirpes respecto a los programas de iluminación, la estimulación lumínica y la intensidad de la luz en cada fase.
Algunas enfermedades también pueden actuar como factores de riesgo de aparición de prolapso. Las enteritis pueden provocar diarrea, irritación cloacal y plumas sucias alrededor de la cloaca, que también favorecerán el comportamiento de picaje. Por otra parte, una inadecuada salud intestinal puede afectar negativamente a la absorción de nutrientes, pudiendo aparecer carencias marginales en los individuos afectados.
Otros procesos víricos como el síndrome de caída de puesta (EDS) y la bronquitis infecciosa provocan debilitamiento del oviducto. Los endoparásitos (vermes y tenias) alterarán la mucosa intestinal, la absorción de nutrientes se verá afectada y además son una fuente permanente de estrés, todos ellos posibles factores desencadenantes de picaje. Algo similar podría decirse de los ectoparásitos: piojos y ácaros son causantes de irritación de la piel y estrés, y su presencia a menudo se asocia a alteraciones de comportamiento y picaje.




Túneles estandard de 10, 12,5 y 14 metros de ancho
másCon de 25 años en el másagropecuario,sector de 550 naves avalanexperiencianuestra

La instalación para sus pollos con resultadosmejoresdel mercado
Gracias a sus condicionesexcepcionales de aislamiento y ventilación y debido a su CALIDAD/PRECIOrelación es un tipo de nave ideal para la cría de cualquier tipo de animal





Aunque la mayoría de las estrategias para la prevención de prolapsos pueden fácilmente deducirse de la descripción de los factores implicados que hemos descrito, a continuación se detallan brevemente algunos consejos:
La detección temprana es esencial: un indicador precoz de la aparición de prolapso es la presencia de huevos con la cáscara manchada de sangre. Por tanto, hay que: permanecer vigilante y observar esto atentamente cuando se recogen y clasifican los huevos.
Visitar los lotes con frecuencia, prestando atención a los sonidos que puedan indicar un comportamiento de picaje severo (graznidos de las aves agredidas), buscando signos de picaje de cloaca y tratando de aislar a las aves heridas
Supervisar la utilización de los nidos, verificando que están en número suficiente para la cantidad de gallinas

alojadas y que sean cómodos y atractivos para las aves. Controlar los horarios de apertura y cierre de los mismos para minimizar la puesta de huevos en el suelo y para evitar que las aves permanezcan demasiado tiempo en los mismos pues ambas situaciones pueden favorecer el picaje de cloaca.
Verificar que el espacio de comederos y bebederos disponible es el adecuado para el número de gallinas alojadas. Si aparecen fenómenos de competencia alrededor de los comederos o bebederos se afectará la uniformidad del lote y se pueden desencadenar comportamientos anómalos y picaje.
Controlar estrechamente el peso corporal y el crecimiento y desarrollo de las aves durante la recría. Evitar que las aves tengan bajo peso o sobrepeso, ajustando el manejo y la alimentación cuando sea preciso.
Tener presente que el momento del estímulo luminoso debe determinarse en función del peso corporal y la uniformidad del lote.
Evitar una fotoestimulación demasiado brusca
Mantener la intensidad luminosa en el interior de la nave siempre que sea posible conforme a las recomendaciones de la estirpe. Utilizar idealmente luces artificiales que puedan ajustarse en intensidad y en el caso de naves abiertas, intentar reducir la intensidad de la luz natural que entra en ellas oscureciendo las ventanas o utilizando cortinas o mallas de sombreo.
Utilizar siempre dietas bien equilibradas, introduciendo los cambios precisos de manera gradual y según las necesidades del lote: en función del peso corporal en la recría y de la masa de huevo producida en producción.
La declaración en otoño de 2022 de dos brotes de influenza aviar de alta patogenicidad (IAAP) H5N1 en granjas de gallinas ponedoras de Castilla-La Mancha supuso el evento más importante de esta epizootia en España por el número de aves afectadas y su ubicación en una zona con elevada densidad avícola.
Directora de ASEPRHU

En uno de los años más cálidos de las últimas décadas en Europa, el virus estuvo activo sin descanso en granjas y en aves silvestres europeas. Algo excepcional, como también lo fue el elevadísimo número de brotes de influenza aviar de alta patogenicidad declarados en la Unión Europea, diezmando su cabaña avícola y la de muchos países terceros. Desde octubre de 2021 hasta septiembre de 2022 se produjeron en la UE 2.550 casos en aves de corral en 37 países. Especialmente grave ha sido la situación en Francia, Italia, Holanda o Hungría.
Pero la alarma subió de nivel cuando las autoridades españolas declararon dos casos humanos positivos a influenza aviar H5N1 entre trabajadores ocupados en la limpieza y desinfección de una de las granjas avícolas positivas. Éstos se hicieron los controles oficiales rutinarios para personas en contacto con el virus y les tomaron muestras (hisopos nasofaríngeos) tras salir de la granja afectada, sin ducharse y con la ropa de trabajo. La noticia de los dos casos positivos se interpretó públicamente como un salto cualitativo en el nivel de riesgo de contagio a personas del temible virus, que ponía en alerta a todo el sistema sanitario, no solo en España sino a nivel global.
Cuatro meses después, el Ministerio de Sanidad ha publicado, en relación a los dos casos humanos declarados, que, a pesar de un resultado positivo inicial en las muestras de ambos operarios, la ausencia de síntomas y la baja carga viral en los dos casos, junto con los resultados negativos de las pruebas serológicas en el primero de ellos sugieren que se trató de contaminaciones ambientales en el contexto de elevada presencia del virus en la explotación afectada.
Esta relevante conclusión oficial que cuestiona la declaración de los casos como positivos no ha tenido, ni de lejos, la repercusión que tuvo en los medios el anuncio inicial. Y es vital su difusión, tanto para el sector y como para todos los profesionales implicados en la estrategia para promover una “única salud” (One Health), que vincula la humana y la de los animales.
La Comisión de Salud Pública publicó también en febrero de 2023 el documento de respuesta y actuación ante la gripe aviar. Incluye, entre otras medidas, un sistema de doble vigilancia para las personas expuestas en granjas a aves y visones infectados, y cribados para mejorar la detección de asintomáticos. El protocolo obliga a comunicar en las 72 horas tras notificar un foco de gripe aviar, la lista de personas que hayan estado en contacto con los animales, para vigilar si tienen síntomas o incluso hacer pruebas PCR. “Dado el alto volumen de aerosoles que se pueden generar en los brotes y en las tareas de limpieza y desinfección posteriores, se considerarán expuestas las personas relacionadas con el foco, incluyendo trabajadores de la explotación y personas implicadas en las tareas de control, independientemente de la utilización de los EPI durante la exposición”, indica el texto.
También se establece un nuevo protocolo de toma de muestras: se recogerán entre 5 y 7 días tras el último contacto de riesgo, antes de comenzar la jornada laboral, tras el aseo personal de las personas expuestas y con ropa distinta de la usada en las labores de la granja, para evitar posibles contaminaciones ambientales. Si no se siguen estas recomendaciones o el cribado se realiza antes de los cinco días desde el último día de exposición, para indicar que un caso positivo se deberán confirmar los resultados positivos de la PCR con una segunda muestra tomada al menos 24 horas después “en condiciones adecuadas”.
El Ministerio de Sanidad ha publicado también la Evaluación Rápida de Riesgo de Gripe aviar A(H5N1), que indica que los protocolos para vigilar y controlar la gripe aviar incluyen los posibles casos humanos relacionados con focos en animales. Y que, aunque éstos pueden llegar a ser graves, la baja capacidad para transmitirse entre personas hace que el riesgo se considere muy bajo para la población general y sigue considerándose bajo para los trabajadores expuestos por su actividad en las granjas positivas con animales enfermos. El riesgo asociado al consumo de carne de ave o huevos es prácticamente inexistente.
Estas últimas actuaciones de las autoridades nos ayudan a prevenir y combatir la influenza aviar y a situar el riesgo para animales y humanos en su justa medida según las evidencias científicas disponibles, por lo que son necesarias y deben ser conocidas por todos.”
María del Mar Fernández PozaLas acciones promocionales, una nueva extensión de norma y el seguimiento de la agenda legislativa, entre los trabajos para este año
El 2023 ha empezado con un calendario cargado de actividades que INPROVO está realizando para el sector del huevo:
La campaña "Hoy, huevo. Alimenta cuerpo y mente", sigue adelante con las acciones previstas; entre ellas, la emisión desde el día 2 de enero de una nueva oleada de la campaña que se emitió en las mismas fechas de 2022, dirigida al mismo público, familias con niños, que en el pasado año.
Se trata de reforzar así los mensajes sobre las ventajas del huevo en la alimentación, destacando que el consumo frecuente (incluso diario) es de interés para nuestra salud física y psicológica. Y también intenta eliminar las reticencias infundadas que aún mantienen algunos padres y madres para incorporar el huevo varias veces por semana en la dieta de sus hijos.
Además, la última asamblea general extraordinaria de la interprofesional del huevo aprobó la propuesta de la junta
directiva para presentar al Ministerio de Agricultura la propuesta de una nueva extensión de norma dedicada principalmente a desarrollar acciones de promoción del huevo y del sector, así como de información y transparencia del mercado y de innovación y formación. Se trata de mantener las líneas de trabajo iniciadas en el año 2020 con la actual extensión de norma, que terminará en agosto de 2023, y prolongarlas hasta el año 2027. El acuerdo de extensión de norma ha recibido el respaldo de las organizaciones del sector que representan a la práctica totalidad del mismo.
En otro orden de cosas, INPROVO está pendiente de la evolución de varias iniciativas regulatorias que afectan a la avicultura de puesta. La implantación de los objetivos previstos en la estrategia "de la granja a la mesa" conlleva la revisión de las normas sobre bienestar de los animales en el transporte y sacrificio, así como la probable eliminación de las jaulas acondicionadas para la producción de huevos y la regulación sobre el sacrificio de los pollitos machos de estirpes de puesta.
También está pendiente la revisión de las normas de comercialización de los huevos. Y la resolución sobre la vacunación de las aves contra la influenza aviar, actualmente en fase de testaje de varias vacunas en la UE. En esta línea, está sobre la mesa la propuesta de la Comisión para reducir los compromisos de gasto en las medidas de control de enfermedades de plantas y animales, en momentos en que la influenza aviar está poniendo en jaque a los productores avícolas de todo el mundo con daños nunca antes vistos.
Todo ello hace prever que el 2023 será un año de gran actividad en asuntos de relevancia para el sector de la avicultura de puesta. Seguiremos informando de los avances en todos estos puntos...

La inflación prevista para el 2022 se reduce en los últimos meses
El Real Decreto-ley 20/2022, conocido como el de "medidas anticrisis" aprobado por el Gobierno en su último Consejo de Ministros del año 2022, y publicado en el BOE del 28 de diciembre concreta algunas de las medidas que se anunciaron previamente para contener los precios de algunos de los productos y servicios que impactan en el Índice de Precios al Consumo (IPC) y afectan a la calidad de vida y a la capacidad adquisitiva de muchos ciudadanos.
Entre ellos, los alimentos básicos, en su mayoría afectados por el IVA superreducido del 4%, como los huevos, la leche o el pan, y los aceites y la pasta, que tienen el tipo del 10%. Los alimentos con un 4% de IVA pasarán al 0%, y pasta y aceite tendrán un 5% de IVA desde el 1 de enero de 2023 hasta el 30 de junio de 2023. Otros, como carnes o pescados (con un IVA del 10%) se han quedado fuera de la medida aprobada por el Gobierno, lo que ha motivado la queja de las organizaciones de productores y de la distribución alimentaria.

No obstante, el tipo impositivo aplicable será el 4 % a partir del día 1 de mayo de 2023 en el caso de que la tasa interanual de la inflación subyacente del mes de marzo, publicada en abril, sea inferior al 5,5 %. En este caso, el tipo del recargo de equivalencia aplicable a estas operaciones será del 0,5 por ciento."
Se añade en el punto 72.3 que "La reducción del tipo impositivo beneficiará
íntegramente al consumidor”, sin que, por tanto, el importe de la misma pueda dedicarse total o parcialmente a incrementar el margen de beneficio empresarial con el consiguiente aumento de los precios en la cadena de producción, distribución o consumo de los productos, sin perjuicio de los compromisos adicionales que asuman y publiciten los sectores afectados, por responsabilidad social.
El registro está operativo el 1 de febrero en la web de la AICA y es obligatorio el 1 de julio de 2023
El Real Decreto 1028/2022, de 20 de diciembre, que desarrolla el Registro de Contratos Alimentarios, desarrolla el registro de contratos alimentarios de carácter digital en el que se deberán inscribir, con carácter obligatorio, los contratos que se suscriban con los productores primarios y sus agrupaciones, en cumplimiento de la ley de medidas para mejorar el funcionamiento de la cadena alimentaria, aprobada en diciembre de 2021.
El registro estará adscrito a la Agencia de Información y Control Alimentarios, que depende del MAPA. El acceso se realizará a través de la página web de AICA desde el día 22 de diciembre, fecha de entrada en vigor de la norma. Para garantizar la operatividad de la aplicación electrónica del registro y asegurar que los operadores puedan contar con los recursos necesarios, la norma aclara que se podrá realizar la inscripción de los contratos alimentarios desde el 31 de enero de 2023, y será obligatorio desde el 30 de junio.

El Registro de Contratos Alimentarios mejora la protección de los productores primarios, ya que facilitará las funciones de inspección y control de la Agencia de Información y Control Alimentarios (AICA) y de las CC.AA., que velan por el cumplimiento de las obligaciones en materia de cadena alimentaria. Se trata de lograr una mayor seguridad jurídica de las relaciones comerciales y una estructuración más eficiente de la cadena de valor.
Están obligados a la inscripción de los contratos alimentarios, según la ley de la cadena, los compradores que formalicen los contratos con los productores primarios y sus agrupaciones.
La inscripción debe realizarse antes de la entrega de los productos objeto del contrato, así como cuando se produzcan modificaciones del contrato pactadas por ambas partes.
Se ha elaborado un documento de preguntas y respuestas frecuentes sobre este registro que está disponible también en la página web de la AICA.
INPROVO y las organizaciones de Francia (SNIPO) y Hungría (BTT) informarán sobre el huevo y el Modelo de Produccion de la UE
La UE ha aprobado el programa europeo de promoción “Los juegos europeos del huevo” (European Egg Games, con acrónimo EUEG), que destacará las características del huevo y del modelo de producción europeo en los próximos 3 años en España, Francia y Hungría.
INPROVO, como coordinador y, como beneficiario del mismo, las organizaciones SNIPO (Francia), y PPB (Hungría), desarrollarán el programa europeo de promoción agroalimentaria en los tres países durante los años 2023 a 2025.

Los objetivos generales de las acciones de información y promoción que se desarrollarán son:
» Aumentar la concienciación y el reconocimiento de los méritos de los huevos de la UE entre los consumidores europeos en relación con las siguientes características:
• Seguridad alimentaria y trazabilidad: controles de animales, piensos y alimentos, buenas prácticas en la manipulación de los huevos.
• Calidad: normas de comercialización (sistema de producción, etiquetado, marcado del huevo...)
• Salud y bienestar animal: controles sanitarios, sistemas de producción y transición a sistemas sin jaula.
• Sostenibilidad
• Aumentar el reconocimiento de los aspectos nutricionales de los huevos en relación a su composición, valor nutricional y declaraciones de propiedades saludables relacionadas con las recomendaciones y directrices dietéticas de cada país.
• Aumentar la competitividad y el consumo de huevos europeos, informando a los ciudadanos para que consuman huevos producidos bajo los estándares europeos.
El presupuesto total del proyecto asciende a 2,2 millones de euros, de los que corresponde a España 1 millón.
La ayuda total aprobada
asciende a 1,8 millones de euros, el 80% del coste, máximo previsto para los programas desarrollados en varios países de la UE.
La campaña mejorará la concienciación de los consumidores sobre el modelo de producción de huevos de la UE (características y costes) y la importancia de los huevos en nuestra dieta para promover una buena nutrición y un buen estado de salud. Ofrecerá a los consumidores la información necesaria para superar las restricciones y la desinformación, para elegir el tipo de huevo que prefieren e incluir más huevos en sus dietas, principalmente en los grupos objetivo de menor consumo: las familias. con hijos y los jóvenes independientes sin hijos.
Estar mejor informado sobre los huevos de la UE ayuda a elegir el tipo de huevo favorito y permite disfrutarlo, además de contribuir a una dieta más sostenible y equilibrada.
El Ministerio de Agricultura, Pesca y Alimentación (MAPA) ha concedido ayudas a 23 proyectos innovadores de interés general en materia de agricultura, ganadería, sector forestal e industria alimentaria, que serán ejecutados en 2023, 2024 y hasta marzo de 2025 por grupos operativos supraautonómicos de la Asociación Europea para la Innovación en materia de productividad y sostenibilidad agrícola (AEI-Agri).
Correspondientes a la convocatoria anticipada de 2022, van a contar con una financiación de 12,15 millones de euros, procedentes de fondos del Instrumento de Recuperación Europeo (Next Generation), incluidos en el Perte Agroalimentario y aplicados al Programa Nacional de Desarrollo Rural 2014-2022 del MAPA.
Entre los proyectos aprobados está el del Grupo Operativo ARTEMIS, denominado
SUSTAINAVILITY: Estudio y evaluación del impacto de prácticas sostenibles y herramientas digitales sobre los sistemas de producción avícola integrando la perspectiva del consumidor y su propensión a pagar
por ellas. Cuenta con un presupuesto total de 599.436,34 €, del que se ha aprobado una ayuda de 594.773,79 €, el importe solicitado.
Este proyecto se enmarca en la línea estratégica dirigida a apoyar la eficiencia en el uso de los recursos, en particular la agricultura de precisión e inteligente, la innovación, la digitalización y la modernización de la maquinaria y los equipos de producción.
¡Enhorabuena al Instituto de Estudios del Huevo y a los demás miembros del Grupo ARTEMIS: Nutreco, Nanta, Avianza, Trouw Nutrition, OCU ediciones y Solid Forest!

EL INSTITUTO DE ESTUDIOS DEL HUEVO LIDERA EL GRUPO OPERATIVO "SUSTAINAVILITY", QUE APOYA LA INNOVACIÓN
La Boticaria García (farmacéutica, divulgadora científica y docente española) visitó el plató del programa "Zapeando", de televisión en La Sexta para aclarar la leyenda injusta que ha demonizado durante años al huevo. Y es que este alimento se hizo viral tras unas declaraciones de Luis Enrique que, durante el Mundial de Qatar, afirmó que había cenado, entre otras cosas, seis huevos: tres cocidos y tres fritos. Además, dijo que el huevo es uno de los alimentos con más nutrientes de largo, "sobre todo, si te aseguras que es de corral."

Boticaria García afirma que "el mito de los tres huevos a la semana viene de un estudio americano de los años 60 que ya está desterrado". "Puedes comer un huevo al día sin problema", y aclara que el límite no es uno. Pero, ¿se puede tomar tantos como Luis Enrique? "El huevo es un alimento muy saludable", insiste la experta que, sin embargo, aunque para una persona que hace mucho deporte como el exseleccionador no es malo, para una persona más pasiva no es aconsejable.

Invita a participar a los profesionales del sector del huevo de España, del 16 al 18 de abril
La próxima Conferencia Empresarial de la International Egg Commission (Comisión Internacional del Huevo) se llevará a cabo en Barcelona del 16 al 18 de abril de 2023.
Su director, Julian Madeley, ha aprovechado esta ocasión para invitar a los operadores
del sector español del huevo a unirse a sus homólogos de todo el mundo. Está prevista la traducción simultánea de todas las presentaciones al español. Y la IEC ofrece a los interesados del sector en España registrarse al mismo coste que los miembros.
Explicarían por qué a veces no basta con extremar la bioseguridad para prevenir la IA
En el estudio publicado el mes de diciembre en la revista Pathogens con el título "Monitoreo de partículas transportadas por el viento que ingresan a las granjas avícolas a través de la entrada de aire: riesgo de virus de la influenza aviar altamente patógena y otros patógenos" describe cómo el transporte de material particulado (MP) con el apoyo del viento contaminado con excrementos de aves silvestres infectadas con el virus de la influenza aviar altamente patógena (HPAIv) puede ser una vía de introducción de HPAIv, lo que puede explicar las infecciones en aves de corral alojadas en interiores.
El objetivo del estudio fue medir la naturaleza y la cantidad de partículas que ingresan a los gallineros a través de las entradas de aire. Las entradas de aire de dos granjas avícolas recientemente infectadas con HPAIv (una granja de pollos de engorde y una granja de ponedoras) se equiparon con bolsas de recolección de mosquiteros. Se recogieron MP cada 5 días durante 25
días. El seguimiento con cámaras de vídeo registró las visitas de aves silvestres. Se analizaron MP para los virus de la influenza aviar (AIV), Campylobacter y Salmonella con PCR
Una cantidad considerable de mosquitos y pequeñas cantidades de PM ingresaron por las entradas de aire, principalmente telarañas y material vegetal, pero no plumas de aves silvestres. Existía una variación sustancial en la entrada de MP entre las entradas de aire. En períodos tormentosos, pueden entrar cantidades significativamente mayores de MP en las entradas de aire dirigidas hacia el
viento. Las muestras de PM fueron negativas para AIV y Salmonella y las muestras de insectos fueron negativas para todos los virus y bacterias, pero varias muestras de MP de pollos de engorde y granjas de ponedoras dieron positivo para Campylobacter. Se observaron visitas regulares de aves silvestres (acuáticas) cerca de los gallineros.
El PM aerotransportado y los insectos, potencialmente contaminados con HPAIv u otros patógenos, pueden ingresar a las entradas de aire de las aves. Se recomienda la implementación de medidas que limiten esta posible ruta de introducción.

La transmisión aérea puede haber desempeñado también un papel en la propagación de los brotes de influenza aviar altamente patógena de 2015 en los Estados Unidos, según este otro estudio.
Los brotes sin precedentes de 2015 de influenza aviar altamente patógena (IAAP) H5N2 en los EE. UU. devastaron su industria avícola y generaron un impacto económico de más de 3 mil millones de dólares. Hoy, la IAAP continúa erosionando las granjas avícolas e interrumpiendo las cadenas de suministro de proteína animal en todo el mundo. La evidencia anecdótica en 2015 sugirió que, en algunos casos, el virus de la IA se introdujo por vía aérea en los gallineros, ya que la mortalidad anormal de las aves comenzó cerca de las entradas de aire de los gallineros infectados.

El estudio modeló las trayectorias del movimiento del aire y las concentraciones de virus que se usaron para evaluar la probabilidad o el riesgo de transmisión por el aire para los 77 casos de HPAI en Iowa. Los resultados muestran que la mayoría de los casos positivos en Iowa podrían haber recibido el virus en el aire, transportado por partículas finas, de granjas infectadas dentro del estado y de los estados vecinos.
Aunque las concentraciones de virus en el aire modeladas en los sitios receptores de Iowa nunca excedieron las dosis infecciosas mínimas para las aves de corral; la exposición continua podría haber aumentado los riesgos de infección en el aire. En el peor de los casos (es decir, tasa máxima de diseminación del virus, tasa de emisión más alta y vida media más prolongada), 33 casos de Iowa tenían > 10 % (tres casos > 50 %) de probabilidad de infección, lo que indica un riesgo medio a alto de transmisión aérea. transmisión para estos casos. La probabilidad de infección por IAAP en el aire podría
verse afectada por el tipo de granja, el tamaño de la manada y la distancia a las granjas previamente infectadas. Y lo que es más importante, puede reducirse notablemente mediante una rápida despoblación y filtración del aire de entrada.
Los resultados de la investigación brindan información sobre el riesgo de transmisión aérea del virus HPAI a través de partículas finas de polvo y la importancia de las estrategias preventivas y de contención, como la filtración del aire y la rápida despoblación de las manadas infectadas.
INTRODUCCIÓN
NING MA Y COL.
THE JOURNAL OF POULTRY SCI.,
59: 3, 223-232
Siendo conocido que el cobre (Cu) es un elemento esencial en varios sistemas enzimáticos como cofactor d una variedad de enzimas intra y extracelulares, aunque los requerimientos de las gallinas en el mismo no hayan sido indicados por el NRC (1994), hemos realizado una experiencia para averiguar si el suministro a las mismas del agua a través de una canalización de este metal en vez de PVC podía afectar a su productividad y su sanidad.
PRUEBA
La experiencia se realizó con un lote de gallinas Hy-Line Brown de 70 semanas de edad, alojadas en baterías, alimentadas con una dieta en base a los requerimientos del NRC, conteniendo 27,1 mg/kg de Cu y manejadas por igual durante 4 semanas. Repartidas en 2 grupos, lo único que variaba entre ellos era la forma de suministro del agua de bebida hasta sus bebederos de tetina, a través de una canalización de PVC en un caso y de cobre en otro, lo que constituyó los dos tratamientos experimentales.
Se exponen resumidos en la tabla adjunta y los dos gráficos que también se acompañan.
En lo referente a la producción, los efectos del contenido en Cu del agua de bebida se manifestaron en una mejor conversión del pienso y del peso de los huevos. Los resultados también indicaron una mejor salud intestinal de las gallinas al inhibirse la colonización de microorganismos patógenos como E. coli y Salmonella, lo que favoreció el enriquecimiento de la variada microbiota cecal.
70 semanas

RESULTADOS
Aunque en ocasiones se han utilizado antioxidantes suplementarios para contrarrestar los efectos de las altas temperaturas sobre las aves, su eficacia puede verse mermada a causa de una menor ingesta de pienso por parte de las mismas. Por lo tanto, la suplementación del agua de bebida con los mismos, durante las épocas de calor, podría ser una mejor que a través del pienso ya que en este caso el consumo de la misma se incrementa, al revés de lo que ocurre con éste.
PRUEBA
Con el fin de probar esta teoría hemos llevado a cabo una prueba con un grupo de gallinas Leghorn, de 27 semanas de edad, repartidas en 4 grupos en otros tantos recintos, bien para ser mantenidas a una temperatura normal, 24 oC, o bien sometidas a otra muy elevada, 34 oC durante 8 h cada día (lotes NT y AT, respectivamente). Y en cada caso o bien recibiendo un agua de bebida sin tratar, aunque filtrada previamente, o bien habiendo sido electrolizada al pasar por un aparato para enriquecerla en hidrógeno (lotes TW y ERW, respectivamente).
El agua de bebida del lote ERW se había tratado con un aparato para disolver hidrógeno desde 6 a 8,5 mg/lit, con lo que su pH variaba entre 7,8 a 9,3 y su potencial reductor de oxígeno (ORP) de 89,4 a 151,2 mV.
La experiencia tuvo una duración de 6 semanas, durante las cuales la alimentación de todas las gallinas fue la misma (normas NRC, 1994), al igual que el fotoperíodo (16 h de luz) y el manejo.
gallinas Leghorn
27 semanas
Se muestran resumidos en la tabla adjunta.
Los resultados positivos del tratamiento con ERW, que se muestran en esta tabla gracias a ello fueron resultado de un alargamiento de la longitud del villus intestinal y de la actividad antioxidante del yeyuno, que habían sido afectadas por la alta temperatura. Por tanto, se puede concluir que este tratamiento constituye un método eficaz para combatir el estrés de las altas temperaturas sobre las gallinas.
(*) Las cifras de la misma línea seguidas de una letra distinta son significativamente diferentes (P < 0,05

La Dirección General de Sanidad de la Producción Agraria del Ministerio de Agricultura, Pesca y Alimentación (MAPAMA) ha publicado el Programa Nacional de control de determinados serotipos de Salmonella en pollos de carne para el año 2023. El objetivo del mismo es controlar la presencia de las bacterias Salmonella enteritidis y Salmonella typhimurium en los pollos de engorde y reducir al 1 % o menos el porcentaje de manadas positivas para estas bacterias.
Su ámbito de aplicación es toda España, en explotaciones de pollos de carne que se destinen a la comercialización, previo sacrificio, aunque no se aplicará a las explotaciones que producen productos primarios destinados al autoconsumo. Las autoridades competentes de las Comunidades Autónomas llevarán a cabo las acciones necesarias para garantizar el control y vigilancia de la salmonelosis de importancia para la salud pública.
Algunas medidas para la notificación y control
Entre otras cuestiones, se establece la obligación de notificar a las autoridades competentes en casos confirmados o sospechosos de Salmonella, tanto si están relacionados o no con programas nacionales de control. También se menciona que las muestras deben discernir entre serotipos objeto de control y otros serotipos de Salmonella.
Los laboratorios y el propietario de la explotación deben comunicar los resultados de los análisis a las autoridades competentes en un plazo de 24 horas, y se indica la responsabilidad del operador de tomar medidas oportunas en caso de detección de serotipos de Salmonella objeto de control, así como la obligatoriedad de grabar los resultados de los autocontroles en una aplicación informática específica. También se menciona la importancia de la identificación de las manadas muestreadas para garantizar una adecuada trazabilidad de
las muestras y el tratamiento informático de los datos de muestreo del programa.
El programa dispone sobre la verificación anual de medidas de bioseguridad en explotaciones avícolas de carne mediante un protocolo oficial y la recopilación de datos en una aplicación informática. Si se observan deficiencias importantes en la bioseguridad, se notificará al titular de la explotación y se dará un plazo para corregirlas.
El veterinario oficial es quien debe adoptar un enfoque proporcionado y progresivo para hacer cumplir las normas de bioseguridad, y la autoridad competente puede tomar medidas sancionadoras como la inmovilización de la explotación o la pérdida de la autorización sanitaria.
PROCAVI INVERTIRÁ 38 MILLONES DE EUROS PARA LA AMPLIACIÓN Y
MODERNIZACIÓN DE SUS INSTALACIONES
Procavi, empresa de producción de carne de pavo e integrada en Grupo Fuertes, va a desarrollar durante los próximos dos años tres proyectos para la ampliación y modernización de sus instalaciones para los que destinará 38 M €.
La compañía, que ha celebrado durante el año pasado su vigésimo aniversario, se encarga de promover procesos de

mejoría destinadas al aumento de la capacidad, a conseguir la máxima eficiencia y la mayor competitividad para seguir siendo un referente en la producción de carne de pavo.
Entre los proyectos ya iniciados se encuentran las obras de ampliación y mejora de sus instalaciones en Marchena, donde se ubica la empresa. Estas obras, a las que se dedicarán 5 M €, se ubican en el área de estabulado de animales, pero se extenderán sucesivamente al resto de fases de producción.
Este año se iniciará además la construcción de la nueva fábrica de piensos en Sierra Yeguas, con un plazo de ejecución de 2 años y una inversión de 30 M €. Con esta actuación, junto a la modernización de toda la maquinaria, se conseguirá doblar la capacidad productiva y lograr una mayor eficiencia desde el punto de vista energético.
Y otro de los proyectos es la construcción de una nueva planta de incubación en Castillo de las Guardas, en un plazo de ejecución de un año y medio y
La Junta Directiva de la Asociación Interprofesional Española de Carne Avícola (AVIANZA) ha elegido a Josep Solé como nuevo presidente. Solé sustituye en el cargo a Antonio Sánchez, presidente desde el 2019.
Asimismo, Jordi Salvador, de PADESA, ha sido elegido vicepresidente en representación de APPE (Asociación de Productores de Pollos de España) y Pelayo Hidalgo como tesorero, en representación de AMACO (Asociación Nacional de Procesadores de Aves, Conejos y Salas de Despiece de Aves) y consejero delegado de Grupo Avícola Hidalgo. Por su parte, Jordi Montfort continuará en el cargo de secretario general de la institución.
El nuevo presidente, cursó estudios de Ingeniería Técnica Agrícola, tiene una trayectoria de casi 30 años en el Grupo Vall Companys, donde empezó en el área porcina y en los últimos quince años ha sido director general del Área Avícola.
El ya presidente de AVIANZA y su nuevo equipo recogen el legado anterior y seguirán trabajando en pro del sector avícola con el

objetivo de fomentar el consumo de carne de ave, poner el foco en la internacionalización del sector (donde se han cerrado acuerdos con la Comisión Europea y se han abierto relaciones con Emiratos Árabes, entre otros) y garantizar la calidad y seguridad de las aves de España a través de un sello de calidad que verá la luz este 2023.
Una interprofesional consolidada
AVIANZA agrupa a más de 65 empresas asociadas y representa a más del 90% de todas las vinculadas al sector avícola de las carnes de pollo, pavo y codorniz. Esto se traduce en más de 5.000 granjas y centros de producción, con 281 salas de despiece y procesamiento, que dan empleo directo a más de 40.000 profesionales.
AVIANZA da soporte a sus asociados en todo lo referente a las relaciones con las Administraciones europeas, la central y las autonómicas, el comercio exterior y los aspectos legislativos. Pero también desarrolla para el sector campañas de promoción y difusión de todos los productos relacionados con las aves, promociona programas de
un presupuesto de 3 M €. Procavi continúa apostando también en I+D+i con el desarrollo de un proyecto de alimentación, mejora de calidad de producto y conservación. En 2022 puso en marcha el proyecto OXIPAVO en busca de la mejora de la calidad oxidativa de la carne de pavo, con el objetivo de aumentar la vida útil de la misma, tanto fresca como elaborada.
I+D que impulsan procesos de innovación y producción sostenible, entre otros.
Asimismo, la asociación se ha convertido en portavoz y medio de transmisión a la sociedad de la situación crítica que vive el sector debido a una serie de acontecimientos que durante estos meses han padecido todos los integrantes de la cadena de producción avícola, como son la subida de los costes energéticos, la guerra de Ucrania con el consecuente encarecimiento de los piensos y la inflación.
La empresa cárnica Cascajares, muy conocida entre otros productos por sus capones, cochinillos y corderos preparados, ha sufrido un duro golpe. Su fábrica en Dueñas (Palencia) ha quedado totalmente destrozada por un incendio a fines de febrero, con efectos devastadores sobre la maquinaria, los ordenadores y los elaborados, aunque no ha habido que lamentar víctimas.

“Es un día muy triste, aunque somos castellanos, gente muy dura. Muy felices porque no ha pasado nada a ninguno de nosotros. Mi única obsesión es levantarnos en el menor tiempo posible para recuperar el empleo y la actividad económica, empezando hoy mismo el nuevo Cascajares, que será mejor que el de ahora y con más fuerza” ha señalado Alfonso Jiménez, presidente de la empresa.
Por su parte, el Consejero de Agricultura de la Junta de Castilla y León, Gerardo Dueñas, al visitar la fábrica quemada apoyó a los propietarios y a los trabajadores, mientras que el Consejo de Gobierno de la misma acordó declarar como “situación de especial y extraordinaria trascendencia y urgente actuación” el incendio sucedido en la fábrica. Entre las medidas que se pondrán en marcha está la declaración de prioritarias y la tramitación con carácter de urgencia todas las actuaciones competencia de la Comunidad necesarias para la reconstrucción de las instalaciones.
Tras el incendio, Cascajares ya está trabajando a tope para intentar volver lo antes posible, si puede ser antes de verano, y, si no, para la campaña de Navidad, han asegurado. Por el momento la empresa ha montado una pequeña oficina en Villanubla (Valladolid), en las oficinas que les ha dejado su operador logístico, la empresa Fernández Centeno, en las que han montado los ordenadores que pudimos salvar, el servidor y los teléfonos.
Asimismo, la compañía está buscando obradores temporales para poder empezar a producir, pero tal y como nos indican “encontrar las máquinas y los obradores no es tan rápido”.
Los responsables de Cascajares se han reunido con los trabajadores para informarles de los proyectos que tienen para intentar volver lo antes posible. Pero mientras se reconstruye, durante unas semanas no va a haber producción, dicen. Y aunque la idea es “estar todos trabajando lo antes posible, en el tiempo que no haya posibilidad la gente tiene que cobrar, por lo que habrá un ERTE, pero durante el menor tiempo posible, porque el objetivo es volver rápido”.
La mayor exposición en instalaciones y equipos Más de 1200 empresas
www.PROultry.com/categorias/aves






de DÍA y RECRIADAS
Doctor Domènech, 4 bajos. 43203 REUS. Tarragona
Tel 977 32 27 27 • Fax 977 33 24 23
E-mail: ruanoavicola@ruanoavicola.com

AVIGAN
S.A.
Casas Blancas
Pollitas recriadas. Recrías en aviario. La experiencia al servicio de la calidad. Apartado 25 - 26200 HARO (La Rioja)
Tel 941 338001 - 941 338003. Fax 941 338356
E-mail: casasblancas@fer.es www.fincascasasblancas.com
Ibérica de Tecnología Avícola, S.A.U Calle Tomás Cerdá, 7 - Parque Tecnológico de Boecillo (Valladolid) 47151
Tlf: (+34) 983 548 163 · Fax: (+34) 983 548 164 www.ibertec.es


www.PROultry.com/categorias/instalaciones-y-equipos




www.PROultry.com/categorias/incubacion




Representante
Representante
Proyectos,
www.victoria-srl.com www.incubatricivictoria.com
INCUBADORAS “LEADER”
Eléctrónicas, 220 V – 50 W para incubar con éxito toda clase de huevos de gallina, pava, codorniz, perdiz, palmípedas, etc.


C/Francisco Medina y Mendoza - Parcela 13, Pol. 1
CABANILLAS DEL CAMPO (Guadalajara) Tel 949 23 28 01 iberica@bigdutchman.com - www.bigdutchman.com
Instalaciones Agropecuarias COSMA, S.L. Políg. Ampliación Comarca I, C/. M, nº 6 31160 Orcoyen (Navarra) • Tel +34 948 31 74 77 cosma@cosma.es • www.cosma.es


Especialidad tipo familiar, semiindustrial y cinegética Desde 10 a 10.000 huevos de capacidad “OFERTA PROMOCIÓN”
Ref. A.0 – 10 huevos 95 Euros










NULLES, Tarragona. España agroleaderSL@gmail.com

Tel.: +34 977 60 09 37 http://avicultura.proultry.com/empresas/leader


LUBING IBÉRICA S.A. Pol. Indus. Bayas Parc. Nido R-40 09200 MIRANDA DE EBRO (Burgos) Tfno. 947 33 10 40 / 41 Email: info@lubing.es


La forma más económica de anunciarse en Selecciones Avícolas

Llama al teléfono 93 792 11 37
para informarte La revista avícola en español leída en más países

Relax: El nidal comunitario para reproductoras pesadas.
Relax es un nidal comunitario automático recien desarrollado por Big Dutchman que se adpata perfectamente a las necesidades de reproductoras pesadas y contribuye a obtener huevos de caldad para incubar.
| Uso de materiales de calidad, esterilla de nidal perforada de plástico. Buena aceptación del nidal.
| 47 cm de profundidad de nidal. Distancias de rodaje cortas para los huevos.
| Construcción bien pensada y sin madera del nidal. Higiene y limpieza óptimas.
| Techo del nidal dividido y muy ligero. Buen control del nidal y de la cinta de huevos.
| Soportes de nidal estables de plástico. No hay riesgo de corrosión.
| Canal de huevos disponible en dos anchos: 400 ó 500 mm, y también con cinta de huevos dividida (2x200 mm).
